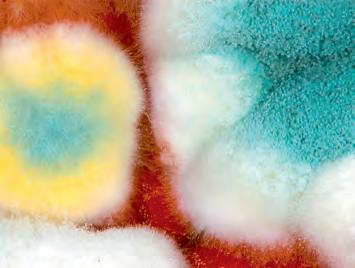

AG Schweiz
GanzheitinGesundheitundBildung
EuropäischeAkademie für Ayurveda

„AyurvedaMedizinund -Therapie“ Ayurveda-Event am28.05.2010



























AG Schweiz
GanzheitinGesundheitundBildung
EuropäischeAkademie für Ayurveda

„AyurvedaMedizinund -Therapie“ Ayurveda-Event am28.05.2010
MasterofScienceinAyurveda-Medizin berufsbegl.HochschullehrgangfürMediziner(MSc) Dipl.Ayurveda-Spezialist* analogOdAKTAyurvedaKomplementärtherapie Ayurveda-Massage/Ayurveda-Therapeut* AyurvedaGesundheits-&Ernährungsberater* PsychologischerAyurveda-Berater * EMRkonform
Seminare&Fortbildungen KursezumKennenlernenundVertiefenderAyurveda-Kenntnisse Ayurveda-Basislehrgang Ayurveda-Fussmassage Ayurveda-Ernährung Vastu–GesundesLebenundWohnen u.v.m. FordernSiekostenlosunserInfomaterial2010an!

AlsanerkanntesKompetenzzentrumPartnerderGujarat AyurvedUniversity,Jamnagar

MitgliedbeimVSAMT–VerbandSchweizerAyurvedaMedizinerund-Therapeuten





8032Zürich Hofstr.53 Tel04426070-70 Fax-71 UmfangreicheSeminardatenbank&Newsletterabo: www.ayurveda-akademie.org

6377 Seelisberg Tel. 041 825 07 00 info@mav-seelisberg.ch www.mav-seelisberg.ch
Die ayurvedische Panchakarma-Therapie ist ein einzigartiges, wohltuendes und tief entspannendes Behandlungskonzept. Äusserst sanfte Reinigungsverfahren lösen schädliche Stoffe aus den Geweben und schleusen sie aus dem Organismus, Geist und Körper werden nachhaltig ausgeglichen.
Heilanzeigen des Maharishi Ayurveda
❑ Vorbeugung,
❑ Schlafstörungen
❑ Frauenleiden
❑ Über- und Untergewicht
❑ Störungen des Herzkreislaufsystems
❑ Stoffwechselstörungen

❑ Abbau von Stress
❑ Allergische Erkrankungen
❑ Gelenk und Wirbelsäulenerkrankungen
❑ Atemwegserkrankungen


Yoga University Villeret
Diplomausbildung des Schweizer Yogaverbandes zum/zur
Beginn: Oktober 2010
■ Mit Diplom des Schweizer Yogaverbandes.
■ Mehr als zehn international bekannte DozentInnen öffnen dasTor in ein neues bereicherndes Berufsleben.
Yoga University Villeret, Rue de la Gare 5, CH-2613 Villeret Tel. 032 941 50 40, Fax 032 941 50 41, www.yoga-university.ch





WasistderGrund,dassimmermehrSpitzen-Weingüter aufbiologischenWeinbauumstellen?Jürgenvonder Mark,MasterofWine,kenntdieAntwort: «InderWeinbereitungsindkaummehrtechnische Verbesserungenmöglich.ZulegenkönnenWinzeraber nochdurchdieUmstellungaufbiologischenWeinbau. Bio-TraubensindbesondersreichanAromastoffen. SieergebenfastvonselbstgehaltvolleWeine.»

ZweieinmaligeGelegenheitenfürSie, ausgesuchteBioweinezutesten.





Biowein ausgesunderNatur
JürgenvonderMarkisteiner derwenigenTrägerdesTitels „MasterofWine“




















InbeidenPaketenenthalten:

Profi-Korkenzieher-Set imWertvonCHF27.--



Ja,ichmöchte35%sparenbittesendenSiemir das Rotwein-Paket mit6FlaschenundProfi-Korkenzieher-SetzuCHF73.-(stattCHF104.20inkl.CHF9.50Porto).DasPortoübernimmtDelinatfürmich. das Weißwein-Paket mit6FlaschenundProfi-Korkenzieher-SetzuCHF70.-(stattCHF101.40inkl.CHF9.50Porto).DasPortoübernimmtDelinatfürmich.
BitteCouponabtrennenundsendenan: Delinat,Kirchstrasse10,9326Horn oderbestellenSieper: Telefon0712276300,Telefax0712276301 E-Mailkundenservice@delinat.com
ProHaushaltundSortenureinPaket.Angebotgültigbis31.März2010odersolangeVorrat.Mit derLieferungerhaltenSieeineRechnung.KeineWeinlieferungenanPersonenunter18Jahren. WirbittenSieumIhrVerständnis.
Strasse/Nr.
PLZ/Ort
Telefon




















DelinatistPionierimbiologischenWeinbau–schonseit30Jahren.AlleWeinestammenaus kontrolliertbiologischemAnbau.Siegehörenzu denBesteninQualitäts-undPreisvergleichen. TestenSieselbst.


Liebe Leserin, lieber Leser
Warum werden wir nach einer Krankheit eigentlich wieder gesund ? Auf den ersten Blick scheint die Frage trivial und die Antwort schnell zur Hand : Es ist natürlich die medizinische Behandlung oder die Therapie, die uns genesen lässt. Doch dass für eine Gesundung auch ganz andere Faktoren verantwortlich sein können oder zumindest mit eine Rolle spielen, zeigt der Artikel des Gesundheitsfachmanns
Kunsthistoriker Juri Steiner so schön formuliert : « Die Kunst ist fasziniert vom roten Motörchen als konkretes Maschinchen und als Emblem, als etwas zwischen Körper und Seele. »
Das Herz ist nicht bloss eine Pumpe, sondern ein Organ, das auch Kunst und Kultur inspiriert.
Martin Koradi ab Seite 14. Eine seiner teilweise provokanten Antworten auf die eingangs aufgeworfene Frage lautet etwa : Wir werden trotz der Therapie, die wir anwenden, wieder gesund !
Dass uns die Gesundheit im wahrsten Sinne am Herzen liegt –oder liegen sollte –, davon handelt die Geschichte ab Seite 10 und auch davon, dass das Herz mehr ist als eine Pumpe, nämlich ein Organ, das Kunst und Kultur seit jeher inspiriert. Oder wie es der
Eine Herzensangelegenheit sind vielen Menschen auch die Spatzen. Wie die Allerweltsvögel im Gefolge des Menschen den Globus eroberten, lesen Sie ab Seite 40. Obwohl die « gefiederten Freunde » irgendwie einfach zu uns gehören, drohen sie mancherorts selten zu werden. Ihnen scheint insbesondere die moderne Bauweise in den Städten zu schaffen zu machen.
Speziell ans Herz legen möchte ich Ihnen überdies die Carte blanche unseres neuen Kolumnisten Simon Libsig auf Seite 66.
Der bekannte Slam-Poet, Autor und Texter aus Baden erzählt dort die Geschichte von Finger-Edi und dessen fragwürdigen Fingerzeigen zu pädagogischen Zwecken.
Herzlich, Ihr

Redaktor
Die gesunde Pflegelinie von Kopf bis Fuss für Sie und Ihn aus den wirkungsvollen Mineralien des Toten Meeres mit Vitamin E, Aloe Vera, Jojoba und weiteren hochwertigen Inhaltsstoffen







ohne Alkohol, Parfum und tierische Fette I pH-neutral, alkalifrei ISO 9001 zertifiziert I ohne Tierversuche entwickelt
Für die schonende Pflege jeder Haut und jeden Alters; auch ideal bei Hautproblemen und Irritationen Gesichts-, Körper-, Haar- & Sonnenpflege, Wellness-, Beauty- und Badeprodukte; Aloe Vera und Aloe Ferox als Gel und Saft; atmungsaktives Coverderm® 24hAbdeck-Make-up (Camouflage) & Kompaktpuder
Bitte senden Sie mir Ihre fundierten, kostenlosen Unterlagen:
Name: Vorname:
Strasse: PLZ/Ort:
Messepräsenz


– Regionale Kulinarik frisch & genussvoll
– Kreative Seminare erfolgreich & inspirierend
– Liebevolle Zimmer erholsam & stilvoll
– Trendige Iglu’s romantisch & abenteuerlich
– Legendäre Meringues unschlagbar & einzigartig
Hotel Landgasthof Kemmeriboden-Bad Familie Invernizzi-Gerber, 6197 Schangnau, Telefon 034 493 77 77 www.kemmeriboden.ch, hotel@kemmeriboden.ch








Gesundheit
8 Mögliche Ursache für den plötzlichen Kindstod
9 Yoga vermindert stressbedingte Entzündungen
10 Das Herz – ein besonderes Organ
14 Warum werden wir eigentlich gesund?
18 Rezepte für gesundes Haar
Beratung
22 Sabine Hurni beantwortet Leserfragen
Haus & Garten
26 Trendgemüse Stachys-Knollen
27 Gartenbewohner Kreuzspinne
28 Mit Naturfarben das Zuhause verschöner n
32 Heinz Knieriemen über Jungfer n in seinem Garten
34 Remo Vetter: Mit Wind und Wetter arbeiten
Natur
38 Trockenwiesen schützen
39 Evolution: Der Baum des Lebens
40 Spatz: Vom Allerweltsvogel zum Sorgenkind
44 Zurück zur Natur: Etang de la Gruère
Leben
48 Aktion «Licht löschen»
49 Espace Jules Verne: Refugium für Science-Fiction
50 Leben auf der Überholspur
54 Die Kohle der Indios wiederentdeckt
61 Öko-Lisa: Letzte Rauchzeichen
Plus
3 Editorial
6 Leserbriefe
58 Leserangebot
60 Agenda 63 Markt
Rätsel 65 Vorschau
66 Carte blanche
Die Versteinerten «natürlich leben» 1-10 Ich bin sehr enttäuscht über den Artikel. Das fängt an bei Äusserungen wie «Übertritte in eine öffentliche Schule können zu Problemen führen». Das Gegenteil trifft zu. Steiner-Schüler sind sehr gerne gesehen und bringen ihre Leistung! Unsere Kinder besuchten die in ihren Augen so komische Schule und haben den Übertritt gut geschafft. Es sind gute kritische Menschen geworden, und mir stossen Phrasen, wie sie im Artikel zu lesen sind, sauer auf. Ich möchte behaupten, der Autor hat keine Ahnung von der Anthroposophie –und trotzdem fühlt er sich kompetent, darüber zu schreiben. H. Maag, per E-Mail
Korrigenda
Den Artikel über «Ein gesunder Start ins Leben» hat Marion Kaden verfasst, nicht wie irrtümlich angegeben Stella Cornelius-Koch. Wir entschuldigen uns für das Versehen. Die Redaktion
Wichtig scheint mir, aufzuzeigen, was hinter der an sich sympathischen Fassade der Anthroposophie steckt, denn kaum ein Mensch fragt sich, an was anthroposophische Bauern, Ärzte und Lehrer glauben, von welchem Unsinn sie überzeugt sind. Von daher betrachtet, finde ich Andres Jordis Artikel sehr wertvoll und notwendig. Allerdings fehlt mir die wesentliche Tatsache, dass Rudolf Steiner so vermessen war, zu behaupten, er sei in früheren Inkarnationen beispielsweise der Plato-Lehrer Kratylos, der Philosoph Aristoteles und der Kirchenlehrer Thomas von Aquin gewesen. Er tat das nicht in öffentlichen Vorträgen oder in seinen zahlreichen Publikationen, sondern gab diese Angaben im kleinen Kreis weiter. Solche Wahrheiten wurden dann nach seinem Tod aufgegriffen und in einigen Sekundärwerken thematisiert. Steiner war mitnichten jener bescheidene und zurückhaltende Philosoph, wie das immer wieder betont wird. Er sah sich als Menschheits-
führer und wurde bereits zu seinen Lebzeiten wie ein Gott verehrt.
Wolfgang Held vom Goetheanum sagt in Jordis Beitrag, dass in der Anthroposophie das freie Urteilsvermögen jedes Einzelnen zähle. Das stimmt so nicht! Was Steiner schrieb und sagte, ist bis heute sakrosankt und darf nicht angezweifelt werden. Äussert man eine andere Ansicht in einer von Steiner vertretenen Sache, wird man subito zurechtgewiesen. Dann hat man das nicht verstanden.
Felix C. Studer, Scherzingen
Es wird immer wieder die Frage aufgeworfen, ob Rudolf Steiner ein Antisemit und Rassist war. Zur Aufklärung über diese Frage kann auf sieben Artikel Steiners in der Zeitschrift Mitteilungen aus dem Verein zur Abwehr des Antisemitismus von 1901 verwiesen werden, in denen er den Wissenschaftsbegriff namhafter Antisemiten seiner Zeit widerlegt und ihre Inkonsequenz in den sonst hochgehaltenen Menschenrechtsvorstellungen entlarvt.
Zu einem Rassimusvorwurf ist meiner Meinung nach entscheidend zu fragen, was Rassismus ist: Die Menschen im Zug einer wissenschaftlichen, entwicklungsgeschichtlichen Analyse in Volksstämme zu unterteilen, die man meinetwegen Rassen nennen kann, ist legitim. Rassismus entsteht erst, wenn man in der Frage, wie die Zukunft gestaltet sein soll, einzelnen Völkern eine übergeordnete Stellung verschaffen will. Spekulationen darüber, welches Volk wahrscheinlich eine zentrale Machtstellung einnehmen könnte, sind davon aber ausgenommen. Solche Spekulationen finden immer noch im Zuge einer Analyse statt und enthalten keine Imperative. Wenn man dieser Rassismuseingrenzung beipflichtet und die unzähligen Aufforderungen Steiners berücksichtigt, ein Geistesleben zu schaffen, welches alle Völker mit einschliessen soll, wird man mir zustimmen, dass ein Rassismusvorwurf auf einer rein sachlichen Ebene unangemessen ist. Andrey Albrecht, Zürich
Briefe an «natürlich leben» Fragen, Anregungen, Lob oder Kritik sind willkommen. Die Leserbriefe müssen mit der vollständigen Adresse versehen sein. Die Redaktion behält sich vor, Briefe zu kürzen. Schicken Sie Ihren Brief per E-Mail, Post oder Fax an: leserbriefe@natuerlich-leben.ch oder: «natürlich leben», Leserbriefe, Neumattstrasse 1, 5001 Aarau, Fax 058 200 56 51
In der Wachstumsfalle «natürlich leben» 1-10
Es hat scheinbar System, die Fotovoltaik kleinzureden. Der Vergleich: 1 AKW gleich 71 Quadratkilometer Solarzellen stimmt nicht. Ich beschäftige mich von Berufes wegen schon lange mit Fotovoltaik und kenne eine Anlage auf einem Scheunendach mit einer Fläche von 587 Quadratmetern, die eine Jahresleistung (nicht installierte Leistung) von 80 0 00 Kilowattstunden (kWh) liefert, obwohl sie in einer nicht nebelfreien Zone steht. Nur die Volllaststunden zu zählen, geht nicht, weil die Anlage bei bewölktem Himmel immer noch rund 40 Prozent ihrer Leistung bringt. Im Mix der Standorte sind es unter 60 Quadratkilometer Fläche, die es für 8 Milliarden kWh braucht. Was hindert uns also daran, auf Zigtausend Dächern Fotovoltaik zu installieren, bevor die Energie zu knapp wird? Für die Natur ist das kein Schaden.
Alfred Schwager, Bächli-Hemberg
Leseraufruf
Für ein Buchprojekt zum Thema «Heilung» sucht die Autorin Nora Haberthür Menschen, die in irgendeiner Weise Heilung von einer schweren Krankheit oder einem Leiden erfahren haben und die bereit wären, ihre Geschichte zu erzählen (auch anonym möglich). Die Heilung kann durch Schulmedizin, alternative Methoden, Geistheilung, Gebet usw. erfolgt sein. Wenn Sie interessiert sind, senden Sie einige Angaben zu Ihrer Geschichte und Ihre Adresse an Nora Haberthür, Frümselweg 11, 8400 Winterthur, E-Mail nora.h@bluewin.ch. Die Autorin erteilt auch gerne weitere Auskünfte.
Der zentrierte Mann «natürlich leben» 2-10 Beckenbodenübungen wirken bei Männern nachweislich bei Erektionsstörungen, aber auch bei Prostatabeschwerden und Inkontinenz. Im Artikel bleibt leider unerwähnt, dass mit Orgawell (www.orgawell. eu) erstmals in Europa eine von Urologen empfohlene Therapie auf DVD verfügbar ist. Der in der Schweiz produzierte Film zeigt Männern anschaulich, wie sie den Beckenboden stärken und ihre Beschwerden erfolgreich behandeln können. Thomas Grether, Davos

Wer kontrolliert eigentlich, ob in einem Produkt Bio drin ist, wo Bio draufsteht? Eine Antwort führt zur bio.inspecta AG. Das Unternehmen mit Sitz im aargauischen Frick ist eine der Firmen, die auch einen grossen Teil der Migros-Bio-Produkte überprüft.
Der Mann hat stets einen skeptischen Blick. Er trägt einen zerknitterten Trenchcoat, aus dem er von Zeit zu Zeit einen Notizblock zückt. Der legendäre Seriendetektiv Columbo klärt Kriminalfälle in Los Angeles auf. Das Einsatzgebiet der Inspektoren von bio.inspecta erstreckt sich hingegen auf Backstuben, Fabrikhallen, Kuhställe, Äcker und Vorratskammern in der Schweiz. Den Notizblock haben auch sie dabei, daneben Gummistiefel, Plastiküberzüge und Kopfbedeckung. Und sie grüssen mit: „Grüezi, Bio-Kontrolle!“
Kontroll- und Zertifizierungsstellen wie die bio-inspecta AG sorgen dafür, dass der Konsument Bio-Produkte erhält, die man ihm als solche verkauft.
Im Auftrag von Labels wie der Knospe von Bio Suisse oder Migros Bio werden die Hersteller, Lieferanten und Verarbeitungsbetriebe überprüft. Ein weites Feld – es reicht vom Bauernhof bis zur Verkaufstheke. Die Inspektoren kommen sowohl angemeldet als auch unangemeldet. Die Kriterien, nach denen sie einen Bio-Betrieb beurteilen, folgen der strengen Bio-Verordnung des Bundes und den Richtlinien privater Labels. Die Migros hat zudem weitere Standards definiert, die für Migros-Bio-Produkte eingehalten werden müssen. „Es wird alles kontrolliert, vom Feld bis auf den



Neues Bio-Logo der Migros
Die Bio-Produkte der Migros werden aus hochwertigen Rohstoffen hergestellt. Die Schweizer Produkte stammen von Landbau-Betrieben, die nach den Richtlinien von Bio Suisse mit der Knospe zertifiziert sind. Import-Produkte entsprechen der europäischen Bio-Verordnung. Die Einhaltung der Richtlinien kontrollieren unabhängige Institutionen. Infos: www.migros.ch




Teller“, umschreibt Ueli Steiner, der Geschäftsführer von bio.inspecta, die Aufgaben seiner Leute. Man kann sich die Bio-Kontrolle wie eine Perlenkette vorstellen. Eine Perle nach der anderen wird aufgereiht. Keine Plastikperle darf unter die Süsswasserperlen geraten. Der Verschluss kommt erst dran, wenn alles stimmt. Eine Bio-Inspektion ist in erster Linie eine Kontrolle des Warenflusses. Sie folgt der Frage: Was kommt rein, was geht raus? Nehmen wir das Beispiel Getreide, das zu Brot wird: Der Bauer, der das Getreide liefert, muss dem Müller neben seinem Bio-Zertifikat die genaue Angabe der Menge vorlegen. In Stichproben wird das Getreide auch auf Rückstände geprüft. Der Müller muss belegen, wie viele Tonnen Bio-Mehl er dem Kunden geliefert hat. Noch von der Theke der Migros-Hausbäckerei aus kann der Inspektor den Weg des Bio-Brotes zurückverfolgen. „Ich befrage oft die Mitarbeiter“, sagt Martin Winistörfer, der für die Kontrolle der verarbeitenden Betriebe zuständig ist. Bäckereien gehören dazu, auch Mühle- oder Fleischerei-Betriebe.
Bei TV-Detektiv Columbo lautet der letzte Satz stets: „Einen Moment, da wäre noch eine Kleinigkeit … nur für meinen Bericht.“ Bei den Inspektoren von bio.inspecta kann er ähnlich lauten, allerdings ohne „nur“.

















































Prävention_ Yoga reduziert Stress
Yoga kann die Reaktion des Körpers auf Stress günstig beeinflussen. Janice Kiecolt-Glaser von der Ohio State University und ihre Kollegen haben herausgefunden, dass Frauen, die regelmässig Yoga praktizieren, weniger Interleukin-6 in ihrem Blut aufweisen. Mit diesem Botenstoff reagiert das Immunsystem auf Entzündungen. Auch Stress lässt den Körper mehr Interleukin-6 produzieren und führt zu Entzündungsreaktionen. Zudem steht die Substanz im Verdacht, bei Herzleiden, Schlaganfällen, Diabetes und Arthritis eine Rolle zu spielen. Für ihre Studie untersuchten die Wissenschaftler 50 Frauen im Alter von 30 bis 65 Jahren, wovon ein Teil fortgeschrittene Yoga-Schülerinnen waren. Diese hatten bereits im Normalzustand tiefere Entzündungswerte. Nach Stresssituationen wiesen sie durchschnittlich über 40 Prozent weniger Interleukin auf. ajo
Regelmässiges Training und richtige Ernährung halten das Herz in Form. Doch das Herz ist mehr als eine blosse Pumpe: ein Organ, das Kunst und Kultur prägt.
Text Regine Elsener

Zahlreich strömte das interessierte Publikum ins Zürcher Stadtspital Triemli: Man feierte 20 Jahre Herzchirurgie mit dem «Tag der herzoffenen Tür». Den Schaulustigen wurde eine Live-Übertragung einer Operation am offenen Herzen geboten; Gross und Klein schlenderte durch ein grosses, begehbares Herz, erlebte hautnah den Puls des Lebens. Das Organ hat eine magische Faszination auf den Menschen. Informationen und vertieftes Wissen haben über die Jahre das Bewusstsein gefördert, dass wir es in der Hand haben, unserem Herzen Gutes zu tun: Wir müssen
es richtig nähren und beschäftigen, sprich: trainieren – auf dass es gross und stark werde.
Diese Erkenntnis ist jedoch noch gar nicht so alt, wie sich der passionierte Läufer Yves Jeannotat, mittlerweile über 80 Jahre alt, erinnert: «Ich liess mich 1959 einmal ärztlich untersuchen», und er kann sich heute ein Lächeln nicht verkneifen. «Der Arzt beschied mir damals, mein Herz sei viel zu gross, das sei sehr gefährlich – ich müsse sofort mit Laufen aufhören.» Was Jeannotat allerdings nicht befolgte, wollte er doch am Murtenlauf teilnehmen. Er kontaktierte in Deutschland den Lauftrainer Waldemar Gerschler und den Kardiologen Herbert Reindell, die ihn beide beruhigten: Sein scheinbar zu grosses Herz sei eine Folge des Laufens und damit des Herzkreislauftrainings.
Vor dem Start zum Murtenlauf musste sich Jeannotat, wie alle Sportler, medizinisch kontrollieren lassen. Das Verdikt: Der Lauf sei viel zu schwierig für ihn, sein Herz schlage viel zu langsam, der Puls sei
viel zu niedrig – er dürfe nicht starten. Jeannotat unterschrieb, dass er den Lauf auf eigene Verantwortung absolviere. «Und ich gewann Murten–Fribourg.» Noch heute läuft er täglich eine knappe Stunde.
Wie jeder Muskel, der trainiert wird, nimmt auch das Herz an Volumen zu; es wird leistungsfähiger und arbeitet ökonomischer: Sein «Arbeitsaufwand», um die nötige Menge Blut in den Kreislauf zu pumpen, verringert und der Ruhepuls senkt sich. Vor 50 Jahren erkannten das noch nicht viele Mediziner. Mittlerweile ist diese Erkenntnis längst etabliert. Nicht von ungefähr werden heute alle –Junge, Alte, Männer, Frauen, ja sogar Kinder – dazu angehalten, ihrem Herzen Sorge zu tragen. Man soll auf die Ernährung achten, Sport und Bewegung in den Alltag einbauen, Laster wie Völlerei, Rauchen, Alkohol und Nichtstun minimieren.
Am besten Intervalltraining
Wie jedes Organ, das nicht gebraucht –oder eben: nicht trainiert – wird, vermindert auch das Herz seine Leistung und ver-

kümmert schleichend. «Inaktivität ist das Schlimmste für das gesunde Herz», betont Urs Boutellier, Professor für Sportphysiologie an der ETH und Universität Zürich. «Ist jemand etwas übergewichtig, jedoch körperlich aktiv, so ist das viel besser als wenn jemand zwar schlank ist, aber physisch faul.» Das ist jedoch kein Freipass für massloses Schlemmen. Auch Boutellier begrüsst es, wenn man seinen überschüssigen Kilos zu Leibe rückt – es bedinge jedoch ein Umdenken: «Wer abnehmen will, muss die Einstellung zum gewohnten Lebensstil in seinem Kopf ändern – dort fängt nämlich alles an.» Das heisst, sich be-
wusst werden, was und wie man isst, respektive wie man seinen Menüplan langfristig umstellt. «Kurzfristige Diäten bringen nichts», sagt der Physiologe. «Zwar ist gesund essen teurer als BilligFood, doch man kann sich durchaus auch mit schmalerem Budget gesund ernähren. Es muss ja wirklich nicht immer Fleisch sein.»
Haben Übergewichtige die Einsicht gewonnen, dass neben dem neuen Essverhalten auch der Sport einen festen Platz im Alltag bekommt, so müssen sie auch hier unterscheiden lernen: «Das gängige Motto, so zu laufen, dass man sich noch miteinan-
Anatomie und Funktion
Rund drei Milliarden Mal schlägt ein Herz während seines Lebens und bewegt dabei rund 250 Millionen Liter Blut durch den Körper. Das Herz entspricht etwa der Grösse der geschlossenen Faust des betreffenden Menschen und wiegt durchschnittlich 300 Gramm. Zusammen mit den Blutgefässen bildet es das Herz-Kreislauf-System. Über das Blut werden die fernsten Körperzellen mit Sauerstoff und Nährstoffen versorgt und es transportiert Kohlendioxid ab. Zwei Drittel des Organs befinden sich in der linken, ein Drittel in der rechten Brustseite. Eigentlich bilden zwei im gleichen Takt schlagende Pumpen das Herz, getrennt durch die Herzscheidewand (Septum cardiale). Es versorgt zwei ineinandergreifende Kreisläufe: Das linke Herz pumpt Blut in den Körper-, das rechte in den Lungenkreislauf.

je nach Kulturkreis war es der Sitz der Seele oder des Denkens, der Vernunft. Noch heute wird das Herz verbunden mit Stärke, Widerstand und Mut, wie ein Blick ins Wörterbuch offenbart: Wir nennen einen Menschen, der unerschrocken, gradlinig und gütig seinen Weg geht, beherzt, grossherzig und herzensgut.
Beide Herzhälften haben je zwei Hohlräume, einen Vorhof (Atrium) und eine Kammer. Die Vorhöfe sind in eine schwache Muskelschicht gehüllt. Im rechten Vorhof sammelt sich das sauerstoffarme Blut aus dem Körperkreislauf, im linken das sauerstoffreiche aus der Lunge. Eine starke Muskelschicht umschliesst die Herzkammern (Ventrikel). Diese pumpen das Blut in die Kreisläufe. Damit es immer in die vorbestimmte Richtung fliesst, verschliessen Herzklappen Ein- und Ausgang der Ventrikel.
der unterhalten kann, gilt nicht für jene, die abnehmen wollen oder müssen», sagt der Fachmann. «Walking beispielsweise genügt nicht, man kann die Zeit für optimaleres Training nutzen.» Folgendes sei angesagt: Abwechselnd intensiv und schnell, zwischendurch langsamer – also diskontinuierlich laufen. Im Sport heisst das Intervalltraining oder Fahrtspiele. Boutellier: «Das bedeutet beim Lauftraining, seiner Kondition entsprechend schnell zu rennen, was den Puls hochtreibt, man darf durchaus ins Keuchen und Schwitzen kommen. Dann drosselt man sein Tempo, bis man es erneut erhöhen kann.» Diverse Studien haben gezeigt, dass Intervalltraining die Fettverbrennung optimal ankurbelt. Und das Herz wird es danken. Auch jenes des schlanken Sportmuffels, wenn er sich endlich aufrafft zu regelmässigen Aktivitäten wie mit dem Velo zur Arbeit zu fahren oder zumindest Teilstrecken zu Fuss zu gehen.
Die Kraft verspeister Herzen
Doch das Herz ist mehr als nur eine Pumpe. Kein anderes Organ hat es geschafft, eine derart verbreitete symbolische Bedeutung zu erlangen wie das Herz. Es symbolisiert die Liebe in all ihren Facetten – die religiöse, erotische, mütterliche, freundschaftliche. Dem Herzen wurden übernatürliche Kräfte zugeschrieben,
Was verleiht diesem Organ, das – gezeichnet, gemalt, geschnitzt, besungen, in Stein gemeisselt und Lyrik geehrt –weltweit in Kulturgeschichte und Kunst verewigt wurde, seinen besonderen Status? «Das Herz ist das einzige Organ, das wir spüren. Mit dem Herzschlag fühlen wir, dass wir leben», vermutet Juri Steiner, Kunsthistoriker und Direktor des Zentrums Paul Klee in Bern. «Wir sind uns hingegen selten bewusst, dass wir ständig eine Leber, eine Niere, eine Milz mit uns herumtragen. Diese Innereien fühlen wir erst, wenn sie uns schmerzen.»
Schon sehr früh erkannte der Mensch, dass dem Herzen Aussergewöhnliches innewohnte. Zu allen Zeiten hätten Kunst und Kunstgeschichte das Herz auf ihre Weise aufgegriffen, ihrer jeweiligen Sichtweise untergeordnet und als Organ und Symbol unterschiedlich interpretiert, so die deutsche Ärztin, Psychoanalytikerin und Kunsttherapeutin Gisela Schmeer. Der frühe Mensch – egal wo auf der Welt – hat laut Schmeer die Funktion dieses grossen Organs in der Brust noch nicht erkennen können. Indes war ihm offensichtlich, dass das Herz härter ist als alle anderen inneren Organe, dass es ein robustes Werkzeug brauchte, um es zu zerschneiden.
Und dieser Widerstand galt damals als Beweis seiner Kraft und diese musste man sich einverleiben, ob von Mensch zu Mensch oder von Tier zu Mensch. Wer das Herz eines Feindes verschlang, verdoppelte seine Kraft und wurde stärker als alle seine Gegner. Das Verspeisen eines Herzens sollte auch die Jugend zu beherzten Kriegern machen.
Dem Herzessen huldigte man aber nicht nur im Kulturraum der südlichen Halbkugel. Auch die Vorfahren europäi-
«Die Kunst ist fasziniert vom roten Motörchen als konkretes Maschinchen und als Emblem.»
scher Völker stärkten sich damit: In der germanischen Edda-Saga verspeist Siegfried das Herz des Drachen Fafnir und kann sich danach mit den Vögeln verständigen.
Das Herz wurde jedoch nicht nur verzehrt, es war auch zur Opfergabe geradezu prädestiniert. Die alten Ägypter etwa bestatteten das Herz getrennt vom mumifizierten Leichnam. Herzbestattungen kannte aber auch das Abendland, insbesondere im 16. und 17. Jahrhundert wurde der Brauch vom Adel gepflegt. Dahinter stand auch die Hoffnung, das Herz möge weiterleben.
Ein besonderer Kult entstand um das Herz Jesu, einer weitverbreiteten Symbolik in der Kunst des christlichen Kulturraumes. Der Kult geht auf die französische Nonne Marguerite-Marie Alacoque zurück, die 1673 eine Vision hatte: Jesus habe sie auserwählt, unter den Menschen die Verehrung des göttlichen Herzens in Gestalt eines «Herzens von Fleisch» zu verbreiten. Liebe und Leid sind die Kennzeichen dieses neuen Kultbildes: Das lodernde, zugleich wunde und blutende Herz soll den Gläubigen ihre eigenen Sünden und die Leidensgeschichte des Heilands ins Gedächtnis rufen.
Der Vatikan indes wehrte sich gegen den neuen Kult, hatte Angst, die kirchliche Instanz verlöre an Boden. Wenn die Menschen und Gott übers Herz so leicht zueinanderfinden, wozu brauchte es dann noch die Kirche und die Fürsprache der Heiligen? Man fürchtete Abweichungen vom rechten Glauben. Knapp 100 Jahre später anerkannte der Vatikan schliesslich den Herz-Jesu-Kult – weil er schon in der ganzen Christenheit verbreitet war.
Die Kunst entriss der kirchlichen Macht das Herz und interpretierte das Symbol vielschichtig. «Die Kunst ist fasziniert vom roten Motörchen als konkretes Maschinchen und als Emblem, als etwas zwischen Körper und Seele», umreisst es Kunsthistoriker Juri Steiner. «Zudem wildert Kunst gerne auf fremden Feldern, wo sie zwar
nicht kompetent ist», sagt er. «Sie ist aber kompetent in der Darstellung, Kunst versteht sich als Amalgam zwischen Welt, Natur und Wissenschaft, sie ist das Bindeglied all dieser Sphären.»
Die Kunst hat sich das Herz einverleibt und in ihrem Gefolge ist das Herzsymbol auch zum gemeinen Volksgut geworden. Mit ihm verkauft die Werbung, es ist auf männliche Oberarme tätowiert, ziert Post-
und Jasskarten, das Rotlichtmilieu bedient sich seiner, Schlager reimen noch immer Herz auf Schmerz – wir sind weit entfernt davon, das Herz nur als blosse Pumpe zu sehen. u
Literatur
_ Wolf-Dieter Storl: «Das Herz und seine heilenden Pflanzen», AT-Verlag 2009, Fr. 34.90

Das schadet dem Herzen... l Inaktivität richtet mehr Schaden als alles andere.
l Übergewicht fördert Folgekrankheiten wie Gefässverengung, zu hoher Blutdruck, zu hohe Cholesterinwerte, Diabetes und Gelenkschäden. Gezielte Gewichtsabnahme beugt diesen Krankheiten vor. l Rauchen führt rund viermal häufiger zu einem Herzinfarkt als Rauch-Abstinenz.
l Stress am Arbeitsplatz oder im sozialen Umfeld wirkt sich direkt aus auf die Hormonausschüttung, den Stoffwechsel und das Herz-Kreislauf-System: Herzfrequenz und Blutdruck steigen, vermehrt gelangen Zucker und Fette ins Blut. ...und das tut ihm gut

l Regelmässige körperliche Aktivitäten können dazu beitragen, dass sich Cholesterinwerte und Blutdruck verbesser n und arteriosklerotische Gefässveränderungen zurückbilden: Der Blutzucker sinkt. Bereits täglich eine halbe Stunde Bewegung mit mittlerer Intensität wirkt sich auf die gesamte Gesundheit positiv aus.
l Fettarme Er nährung, dafür reich an Obst, Salaten, Gemüsen, Getreideprodukten und Hülsenfrüchten. Statt tierischem Fett hochwertige Oliven- und Rapsöle verwenden. Weniger Fleisch, öfter Geflügel und Fisch. Salz und Zucker reduzieren. Die sogenannte Mittelmeer-Diät senkt laut Studien das Risiko für Herz-Kreislauf-Erkrankungen. l Glimmstängel weglegen, zumindest reduzieren.























































































Den Leuten ist es offenbar wichtiger zu wissen, was auf meinem Kopf ist, als was in meinem Kopf ist», soll eine unserer Bundesrätinnen in einem Interview einmal gesagt haben. Während bei Männern die Frisur nur in seltenen Fällen ein öffentliches Thema ist, machen sich viele prominente Frauen ihr Haar zum Markenzeichen. Zu recht. Denn das Haar unterstreicht die Persönlichkeit und leistet einen Beitrag zum selbstbewussten Auftreten. Zumindest solange es kräftig, gesund und schön ist. Denn Stress, Erschöpfung, Blutarmut, Eisenmangel, hormonelle Schwankungen, Darmentzündungen, Krankheiten oder einseitige Diäten können dem Haar stark zusetzen. Sie werden dünner, lassen sich schlechter frisieren oder fallen aus. Oft entwickelt sich ein Haarausfall schleichend. Nach und nach bleiben morgens mehr Haare auf dem Kopfkissen liegen, in der Bürste hängen oder lösen sich beim Waschen.
Gut versorgt von innen

Die insgesamt etwa 100 0 00 bis 150 0 00 Kopfhaare gehören, ebenso wie die Nägel und die Körperhaare, zu den Hautanhanggebilden. Das Kopfhaar besteht aus drei Teilen. Dem Haarschaft, der Haarwurzel und der Haarzwiebel. Zu reden gibt vor allem der Haarschaft. Er ragt mal blond, mal fein, mal lockig und kräftig aus der Haut heraus. Tief in der Haut verankert liegen Wurzel und Zwiebel. Letztere bildet ständig neue Haarzellen, die für ein kontinuierliches Wachstum des Haares sorgen. Zu jedem Haar gehören zudem eine Talgdrüse, eine Nervenfaser und ein Haaraufrichtemuskel.
Damit die Haare kräftig und gesund nachwachsen, brauchen sie Pflege. Nicht nur von aussen, sondern auch von innen.
Nährstoffe wie Vitamin B1 (Thiamin), L-Cystin und Keratin versorgen die Haarwurzeln über das Blut mit neuer Kraft. Fehlen diese Nährstoffe in der täglichen Kost, kommt es früher oder später zu einer ungenügenden Nährstoffversorgung der Haarwurzeln.
Es kann aber auch vorkommen, dass die Blutzirkulation abnimmt, zum Beispiel im Alter. In diesem Fall sind die Nährstoffe zwar in genügender Menge vorhanden. Sie erreichen jedoch die Haarwurzeln nicht oder nur unzureichend. Ein weiterer Faktor, der die Versorgung beeinträchtigen kann, ist der erhöhte Nährstoffbedarf in Stresssituationen: Bis das Blut bei den Haarwurzeln angekommen ist, haben andere Organe die Nährstoffe bereits für sich beansprucht.
Werden die Haarwurzeln aus einem dieser Gründe nur ungenügend mit Nährstoffen versorgt, kann sich daraus mit der Zeit der diffuse Haarausfall (in der Medizin als Alopecia diffusa bezeichnet) entwickeln. Weitere Formen von Haarausfall sind der kreisrunde Haarausfall (Alopecia areata) sowie der erblich-hormonell bedingte Haarverlust (Alopecia androgenetica), der bei den Männern zuerst zu den Geheimratsecken und später zur Glatzenbildung führt.
Erblich bedingter Haarausfall lässt sich nicht aufhalten oder rückgängig machen. Der diffuse Haarausfall sowie der kreis-


TAICHI&QIGONGSCHULE
PietHaeuser|www.tqz.ch|0413700791
TaiChiAusbildung startMai2010
QiGongAusbildung startMai2010 Kursprogrammbestellen!

www.kriya.ch
Einführungs-undFerienkurse indieMeditationstechnik nachderTraditionvonBabaji, ParamahansaYogananda(Autor von«Autobiographieeines Yogi»)bisYogiDhiranandaji
Zürich/Zollikon: 13./14.März, 12./13.Juni 2010
Südtirol: 17.–24. Juli2010
Schwarzwald: 9.–16 Oktober2010
2_Christen_Dinkel_bearb.qxp 29.7.2009 9
Kursleitung: BarbaraGlauser-Rheingold, autorisierteKriyaYogaLehrerin Information: SabineSchneider, Tel.0443502189,sabine.schneider @ kriya.ch
Tai Ji - Ausbildung ab 6. März in Winterthur
Qi Gong - Ausbildung ab 20. März in Zürich
Beide Ausbildungen SGQT-anerkannt (Schweiz.Berufsverband)
QiSpace – Tai Ji & Qi Gong Schule
Helen Waldmeier und Daniel Züblin
Tel. 052 624 50 60 www.qispace.ch
Viele Gesundheitsprobleme können mit kieselsäurehaltigen Ur-Dinkelspreu-Matratzen,-Auflagen, -Kissen und -Steppdecken im tiefen Schlaf gelöst werden.
Hilfreich bei Nasen-,Neben-,Stirnhöhlenproblemen,Kopfschmerzen,Ohrensausen.Stimuliert Durchblutung und Reflexpunkte im Ohr. Detaillierte Gebrauchsanweisung
Rücken-,Schulter-,Gelenkprobleme,Schlafstörungen, Krampfadern,restless legs.Neurodermitis,Asthma, ADHS,Blutdruck,Depressionen.Stärkung des Immunsystems.Keine Milbenbildung,Abschirmung gegen Störfelder,Wasseradern und Elektrosmog.Spezialkissen gegen Kopfweh,Migräne,Schleudertrauma, Nackenverspannungen,Venenentzündungen,Tennisarm,zur Geburtshilfe.Kindermatratzen,Edelhaarduvets aus Kamelflaumhaar oder Seide.
Stückpreis Fr.7.–,Min.-Best.6 Stück,14–24 St.Fr.6.–, ab 26 St.Fr.5.–Mengenpreise auf Anfrage.(Versandpauschale Fr.9.–).
Für bessere Lebensqualität
2_Weyermann_Koerperarb_bearb.qxp 30.1.2 0 INTERNATIONAL I NSTITUTE FOR C RANIOSACRAL B ALANCING ®
KörperfreundlicheNaturmaterialien sorgenfüreinenbesseren Temperatur-undFeuchtigkeitsausgleichundgarantierenein gesundesSchlafklima.
Natürlich Komfortabel


SchönemoderneBetten auseinheimischemMassivholz undkuscheligeBio-Bettwaren.
WirfreuenunsaufIhrenBesuch! (AuchLieferungundVersand.)
WECHSELJAHRE
18.02.2008 - 22.02.2008
Grundausbildung Craniosacrale Biodynamik
KRAFT DER STILLE 21.03.2008 - 24.03.2008

3-JÄHRIGE QIGONG AUSBILDUNG
Start 19.04.2008
Hopi-Ohrkerzen,Postfach 22 6052 Hergiswil, 079 659 15 62
ALBERT CHRISTEN www.leony-bettlach.ch CH-2544 Bettlach,Tel.032 64512 87,Fax 0326451288

IhreOTMARSAN-Trink-Fasten-Kurunterstützen wirpersönlichmitfrischenSäften,Massagen, täglichenWickeln,Fussbädern,Dampfbädern, Sauna,Wanderungenu.v.m..GeniessenSiedie ruhigeundentspannteAtmosphäre! WohlfühlwocheabCHF295.–proPerson.
MayaBachmann-Krapf CH-6353Weggis Telefon0413920010 E-Mailinfo@otmarsan.ch
3-jährige berufsbegleitende Weiterbildung in körperzentrierter Beratung und Körperarbeit im Wasser KiW Beginn:4.September 2010 in Orta www.integrativekoerperarbeit.ch Denise Weyermann, 079 459 1404 IKA-Handbuch: www.kairosverlag.ch
• P.+M.Müller • Kniestrasse29 8640Rapperswil Telefon0552111066 vitalana@bluewin.ch www.vitalana.ch
32068-02
TaiChi & QiGong Schule Piet Haeuser www.tqz.ch
AktuelleTermine: Einführungskurse2008 Zürich/Stadt•01.03.–02.03. Zürich/Stadt•12.04.–13.04. Intensivausbildung2008 Zürich-Männedorf•02.05.–09.05.
WirsendenIhnengerneIn
InstitutfürKlang-Massage-Therapie Industriestrasse32•CH-5600Lenzburg Tel.0041(0)6289205-58•Fax89205-62
Das angenehme,entschlackende Darmbad
• ideal gegen Blähungen und Verstopfung
• beste Vorbereitung und Begleitung einer Fastenkur
• Verdauungsstörungen
Ich freue mich auf Ihren Anruf zur Anmeldung oder für weitere Informationen.

Ursula Wachter Krankenpflegerin/Colonhydrotherapeutin Marktgasse 3 c/o Physiotherapie Hondema 5436 Würenlos 056 424 35 71 www.colon-therapie.ch
> Wohlfühlwoche
INFORMATION & ANMELDUNG: mit Bhadrena Tschumi Gemin und Kavi Gemin www.icsb.ch – info@icsb.ch Tel.03130130 42, Fax 0313016791
Mitglied des Schweiz. Verbandes Cranio Suisse ® Seminar 1 29. 3. 2010 – 5. 4. 2010 Informationsabend: 15. 2. 2010







Massageliegen MassageStühle HotStone


21.9.08DeniseDisler,CH AuraSoma
z.B. ModellHawaii mitextraabgerundetenEckenundtief eingerücktenBeinen
Zentrumfür sensitiveWahrnehmung Zweierstr.106,8003Zürich www.sensitiv-coaching.ch,Tel.0444510055

www.klang-massage-therapie.ch 31783-02 32281-02

TAOTRADE, MittlereStr.151,4056Basel,info@claptzu.ch Tel.0613813181,Fax0613838492,www.claptzu.ch
30609-02
– EnergyHealingTraining Vorträgeinkl.Demo inenergetischerOrganchirurgie:8.3.Winterthur; 9.3.Landquart;10.3.Zürich;11.3.St.Gallen; 15.3.LachenSZundweiterenDatenimTessin.
– EHT:BasisundAufbausowieAusbildung ingeistig,energetischemHeilenbeiZürich.
Die Schule für Tanz- und Bewegungstherapie
Körper – Tanz – Bewegung – Kunst –Wahrnehmung – Ausdruck – Gespräch Biografiearbeit Persönlichkeitsbildung Sozialkompetenz
Einsatzmöglichkeiten in Pädagogik – Kunst –Prävention – Therapie
Laufend:Schnupperwochenenden –Fort- und Weiterbildungen – Kursangebote Infos: 043 333 99 70 oder www.tanz-prozess.ch
-Schulmedizin150,200,600Stunden FüralleAusbildungender Komplementärmedizin -TraditionelleChinesischeMedizin Grundlagen,Akupunktur,Tui-Na -TraditionelleEuropäische Naturheilkunde(TEN) -WestlichePflanzenheilkunde -Reflexzonenmassage BesuchenSieunsereInfoabende: 4.5./1.6./24.8./26.10.2010inBern SAKEBILDUNGSZENTRUM,3014BERN Tel.0313523544,www.sake.ch
32128-02
5. - 9.3.’08 Beginn der zweijährigen Grundausbildung. Ort: Damvant, JU
Teil1: 26.–28.März,Teil2:23.–25.4.10usw. Neu auchinLocarno/Tessin,Beginn:7.–9.5.10 EHTHerbstbeginnbeiZürich:17.–19.9.10
– Intuitionstraining 26.+27.4.&31.5.+1.6.10
– WeisheitimHerzenderEssenz 17.–22.7.10
– DeinwahresWesenfinden 11.–16.10.10

Institutfür AngewandteIntuition
JoyF.Barbezat CH-6597Medoscio Tel.0918592359 info@energyhealing.ch www.energyhealing.ch
Acht Tore zur weiblichen Ganzheit –Ein schamanischer Heilungsweg 32158-02
Gesundheitsprodukte direkt aus den USA –viel BILLIGER!!!
Diät Produkte Vitamine

Haben Sie Fragen?
Sabine Hurni, Drogistin HF und Naturheilpraktikerin mit Fachrichtung Ayurveda und Phytotherapie, und das kompetente «Natürlich»-Berater-Team beantworten Ihre Fragen zu Gesundheit, Ernährung, Ökologie, Garten oder Natur.
Senden Sie Ihre Fragen an: sabine.hurni@natuerlich-leben.ch oder «Natürlich», Leserberatung Neumattstrasse 1, 5001 Aarau
Beratung per Internet Fragen können Sie auch auf unserer Website www.natuerlich-leben.ch stellen. Das «Natürlich»-Berater-Team ist unter der Rubrik «Beratung» auch online für Sie da.
Beim Wandern habe ich oft kraftlose Beine. Am schlimmsten ist es nach einer Rast. Irgendwie «fliesst» es nicht richtig. Ich habe wenig Eisen und nehme Nahrungsergänzungen – ohne Erfolg. Wie kann ich mir helfen?
U. A. Zeihen
Die Schwäche in der Beinmuskulatur kann viele Gründe haben. Die Muskeltätigkeit hängt stark mit Mineralien zusammen. Magnesium, Kalzium, Kalium und Eisen sorgen für ein gesundes Muskelspiel. Es könnte sein, dass die Nahrungsergänzungen nur Vitamine enthalten und die Mineralstoffe zu kurz kommen. Fehlen wichtige Mineralstoffe und Spurenelemente, neigen die Muskeln zu Verkrampfungen. Zudem verschiebt der Mangel an Mineralstoffen den SäureBasen-Haushalt in den sauren Bereich. Körperübersäuerung schwächt die Muskeln und führt zu schneller Ermüdung. Ich würde gleichzeitig von innen und von aussen an die Sache rangehen. Äusserlich wären Beinmassagen angezeigt. Entweder massieren Sie sich selber täglich die Beine mit wärmendem Arnika- oder Calendula-Öl oder Sie gehen ab und zu in eine Massage. Es kann sein, dass gewisse Muskelstränge derart verhärtet sind, dass deren Kraft viel zu schnell aufgebraucht ist. Versuchen Sie auch warm zu essen und vor dem Wandern vielleicht ein warmes Frühstück einzunehmen.
Sabine Hurni
Ich würze meinen Kaffee gerne mit Kardamom. Ich habe gehört, dass das Gewürz das Koffein im Kaffee neutralisiert. Wissen sie etwas darüber?
Christine Haldemann, Riedholz
Beduinen würzen ihren Kaffee oft mit Kardamom, um das Koffein zu neutralisieren. Diese Wirkung beruht auf langem Erfahrungswissen, ist aber wissenschaftlich nicht untersucht worden. Die
Zubereitung erfolgt in einem speziellen Ritual, das als Symbol der Gastfreundschaft gilt. Es werden dem Kaffee entweder einige Körner Kardamom beigegeben oder dieser wird gemahlen beigefügt, wobei dann häufig der gezuckerte Kaffeesatz gegessen wird. Gemahlener Kardamom oder ein Gemisch mit Koriander bereichern auch Teemischungen oder können für Gebäcke und Süssspeisen verwendet werden. Für die Herstellung von anregenden Elixieren und berauschenden Aphrodisiaka wurden immer wieder die gleichen Gewürzkombinationen angegeben, die aus dem indischen Subkontinent über den Orient nach Europa gelangten. In den orientalischen Liebeslehren und im Ananga Ranga, dem indischen Buch der Liebeskunst, wird dem Kardamom eine besondere Bedeutung als Entfacher der Liebeslust, aber auch des Ausgleichs zugeschrieben.
In der indisch-ayurvedischen Medizin gelten die Samen des Kardamoms als speicheltreibend. Der Speichel, der Schlüssel für eine geregelte Verdauung, spielt nach ayurvedischem Verständnis eine wichtige Rolle. Kardamom ist magenstärkend, harntreibend, milchbildend – er regt das Verdauungsfeuer an, erfrischt den Geist und stimuliert die Herztätigkeit. Bei reich-

lichem Genuss von Knoblauch, Alkohol oder schlechtem Mundgeruch hilft das Kauen einiger Kardamomsamen.
Heinz Knieriemen
Zu hoher Blutdruck
Seit einem halben Jahr leide ich vermehrt an Bluthochdruck. Kann eine Blutdrucksenkung mit einem natürlichen Präparat erreicht werden? Kann es auch wieder abgesetzt werden? S. A. Binningen
Ich stelle Ihnen eine Gegenfrage: Wie haben Sie es geschafft, dass Ihr Blutdruck im letzten halben Jahr gestiegen ist? Vielleicht gibt Ihnen die Antwort darauf gleich einige mögliche Ansätze, wie Sie Ihren Bluthochdruck angehen könnten. Es gibt zahlreiche natürliche Heilmittel, die den Blutdruck günstig beeinflussen, zum Beispiel Knoblauch, Ginkgo oder Misteln. Knoblauch und Ginkgo gibt es vor allem als Tabletten, Misteln erhalten Sie als Tinktur. Diese Heilmittel verbessern die Blutfliesseigenschaften und erweitern die Arterien auf sanfte Weise. Die Mistel sorgt zudem für einen Spannungsausgleich in Stresssituationen.
All diese Heilmittel können Sie jederzeit wieder absetzen. Bleiben Sie aber trotzdem in ärztlicher Kontrolle. Wichtig ist, dass Sie generell genug Wasser trinken und täglich Obst und Gemüse essen. Mit dem Wasser schwemmen Sie Stresshormone aus, und die Früchte versorgen den Körper mit basischen Mineralsalzen, die einen wichtigen Ausgleich zur eher eiweiss- und kohlenhydratreichen Ernährung schaffen. Auch erhitzende Lebensmittel wie Kaffee, Alkohol und scharfe Gewürze sowie Nikotin können den Blutdruck erhöhen. Letztlich gehört alles zusammen. Deshalb sind auch die Ursachen für hohen Blutdruck an verschiedenen Orten zu finden. Eine solche Diagnose kann auch eine Aufforderung sein, mal innezuhalten und seinen Lebenswandel zu reflektieren. Sabine Hurni
Was bedeuten Muttermale? Kann man etwas dagegen tun?
Eveline Klaus, Brugg
Fast jeder Mensch hat vereinzelte oder zahlreiche Muttermale. Es sind gutartige, lokale Ansammlungen von pigmen-
tierenden Hautzellen, sogenannten Melanozyten. Deshalb werden die Muttermale im Sommer an der Sonne eher noch etwas dunkler. Aus ayurvedischer Sicht geben sie einen Hinweis auf den Pitta-Anteil eines Menschen. Ein Pitta-Typ hat in seiner Grundkonstitution relativ viel Hitze. Damit sich Pitta-Typen wohlfühlen und gesund bleiben, ist es wichtig, dass sie allzu erhitzende Speisen (Chili, Meerrettich), Tätigkeiten (Sauna, Joggen im Sommer, Rauchen, Kaffee trinken, Sonnenbaden) und feuchtwarme Weltgegenden eher meiden. Gleichzeitig müssen sie einen Ausgleich mit kühlenden Elementen schaffen. Überspitzt gesagt sollten Pitta-Typen im Sommer im Schatten sitzen, Pfefferminztee trinken und Früchte essen.
Gegen die Entstehung von Muttermalen können Sie nichts machen. Wichtig scheint mir einfach, dass Sie den Wärmehaushalt im Gleichgewicht halten, indem Sie allzu Erhitzendes vermeiden, im Frühling jeweils die Leber mit Mariendisteltropfen aktivieren und viel Früchte und Gemüse essen statt Wurst und scharfen Käse. Es gibt natürlich Methoden, um die Muttermale zu entfernen. Zum Beispiel mit Laserbehandlungen. Das macht dann Sinn, wenn die Muttermale an exponierten Stellen wie am Hals oder im Gesicht auftreten und die Betroffenen stark darunter leiden. Um mehr darüber zu erfahren, suchen Sie am besten einen Hautarzt auf.
Sabine Hurni
Basenbäder selber machen
Kann man eigentlich kostengünstig auch selber einen Badezusatz für ein Basenbad kreieren?
Rolf Menke, Effretikon
Das kostengünstigste Basenbad wäre eine normale Seifenlauge. Alle Seifen sind basisch. Ihr pH-Wert liegt weit über 7. Würden Sie allerdings eine halbe Stunde darin baden, würde das den Säureschutzmantel der Haut vorübergehend beschädigen. Es würde eine gewisse Zeit dauern, bis der Körper wieder genügend freie Säuren nachgeschoben hätte, um den Schutz wieder aufzubauen. Ähnlich, aber in abgeschwächter Form, funktionieren die Basenbäder. Ihr pH-Wert liegt aber bloss leicht im alkalischen Bereich. Gleichwohl muss der Körper auch hier den Säureschutzmantel der Haut wieder aufbauen.
Bei unserer säurelastigen Ernährungsweise erreichen Sie mit baden allein aller-

dings nicht viel. Nötig wäre vielmehr eine Umstellung der Ernährung oder die Einnahme von Mineralsalzen. Das heisst: mehr Gemüse, Früchte, Nüsse und Trockenobst (Rosinen sind die Spitzenreiter unter den Basenbildnern). Und entsprechend weniger Eiweisse (Fleisch, Milchprodukte) und Kohlenhydrate (Weizen, Gebäck). Das freut auch gleich die Nieren und die Leber, weil diese Organe durch den Eiweiss- und Kohlenhydratkonsum ziemlich gefordert sind.
Ich empfehle Ihnen zudem Meersalzbäder; die sind einfach und kostengünstig herzustellen. Meersalz regt die Durchblutung an und reinigt den Körper energetisch. Wenn Sie vorher noch eine Tasse Kräutertee trinken und ein paar Rosinen knabbern, haben Sie den basischen Effekt ebenfalls. 100 Gramm Salzgranulat (erhältlich in jeder Drogerie oder Apotheke als Badesalz), 5 Tropfen natürliches, ätherisches Öl und 1 bis 2 Esslöffel getrocknete Kräuter oder Blüten ins Badwasser geben. Beim Öl und bei den Blüten können Sie beliebig experimentieren. Lavendel wirkt entspannend, Zitrone stimmungsaufhellend, Rosenöl ist beruhigend und Rosmarin regt die Durchblutung an. Sabine Hurni
KampagnefüreuropäischeGütesiegel–g.U.,g.g.A.,D.O.C.inderSchweiz
SüdtirolerSpeckg.g.A.,AsiagoKäseg.U.undSüdtirolerWeinD.O.C.sinddreieigenständige Produkte,dieindensüdlichenAusläufernderAlpenreifen.ImBestrebenderEU,Produktemit europäischenGütesiegelnzufördern,werdendiesedreinorditalienischenSpezialitätenin dergemeinsamenKampagne«Unique!Alpin-mediterranerGenussmitgarantierter Herkunft»inderSchweizbeworben.
DieEUfördertlandwirtschaftlicheQualitätsprodukte,die aufgrundihrerspezifischen Eigenheitenmiteuropäischen Gütesiegelnausgezeichnetwordensind.SüdtirolerSpeckg.g.A. (geschütztegeografischeAngabe), AsiagoKäseg.U.(geschützteUrsprungsbezeichnung)undSüdtirolerWeinD.O.C.(DenominazionediOrigineControllata)sind solcheeuropäischenSpezialitäten. AlsBotschafterallereuropäischen Gütesiegelwerdensieinder SchweizimRahmeneinerdreijährigenInformationskampagne beworben.Finanziertwirddie KampagnevonderEuropäischen Kommission,demitalienischen Staat,demConsortiumSüdtiroler Speck,demConsorzioTutelaAsiago,sowiedemVerbandderKellereigenossenschaftenSüdtirols.
«Genuss-Schatzkammer» Europa
EuropaverfügtübereinenimmensenReichtumanLebensundGenussmittelnvongarantierterHerkunft,odertypischer Verarbeitung.Umsowohldie KonsumentenalsauchdieseeuropäischenSpezialitätenvorunlautererKonkurrenzdurch«Nachahmer-Produkte»zuschützen, hatdieEUschon1992besondere Herkunftsbezeichnungeneingeführt.DieKampagne«Unique! Alpin-mediterranerGenussmit garantierterHerkunft»stelltdrei diesereuropäischenSpezialitäten mitgarantierterHerkunftvor, dieeineGemeinsamkeithaben: SiereifenamSchnittpunktvon nördlicherundsüdlicherGenuss-






ReifenindensüdlichenAusläufernderAlpen: SüdtirolerSpeckg.g.A.,AsiagoKäseg.U.undSüdtirolerD.O.C.Wein

kultur,ineinemKlima,dasgleichermassenvonfrischenAlpenbrisenundwarmenLuftmassen ausdemmediterranenRaum geprägtwird.
ImAlpenklimagereift
SüdtirolerSpeckg.g.A.wirdnicht sostarkgeräuchertwiedieSchinkenimNordenundnichtsomild wiediejenigenimSüden.Wenig Salz,wenigkalterRauch,vielfrischeLuftundeineindividuelle Gewürzmischungprägenseinen Geschmack.Asiago-Käseg.U. wirdindennorditalienischen RegionenTrentinoundVeneto hergestellt.Kurzgereifter«Asiago Fresco»schmecktmildundfrisch,
«AsiagoStagionato»dagegenist einewürzigeSpezialität,dieals «Mezzano»(mindestens4Monategereift),«Vecchio»(mindestens10Monategereift)oder «Stravecchio»(mindestens15Monategereift)aufdenMarkt kommt.ImSüdtirolreifenauf 5122Hektar(davonsind98ProzentD.O.C.klassifiziert)rund20 verschiedeneTraubensorten. DankdemgrossenSpektruman BodentypenundMikroklimen bringendieWinzer-(innen)eine VielfaltanTopweinenhervor, dieeinzigartigistinItalien.
WeitereInfosauf www.alpin-mediterran.ch







ImRahmenderKampagne hatderZürcherSpitzenkoch FelixEppisser(16GaultMillau Punkte)einRezeptbuchmit 25Gerichtenentwickelt,die mitAsiagoKäseg.U.und SüdtirolerSpeckg.g.A.zubereitetwerden.Dazuempfiehlt erSüdtirolerDOCWeine. DashandlicheRezept-Booklet kannkostenlosbei info@alpin-mediterran.ch bestelltwerden.
Verhärtete Muskeln
Ich leide seit der Geburt meiner Tochter vor über zehn Jahren an Schmerzen der ganzen linken Körperseite. Meine ganzen Rückenmuskeln sind verhärtet. Yoga, A kupunktur und Osteopathie helfen nur kurzfristig.
M. W., San Miguel (Argentinien)
Wie Sie die Situation schildern, könnte das Problem mit der Geburt Ihrer Tochter zusammenhängen. Es kann vorkommen, dass bei einer Geburt das Kreuzbein blockiert wird. Das hat natürlich Auswirkungen auf den ganzen Rücken. Schliesslich bilden das Becken und das Kreuzbein die Basis für die gesamte Wirbelsäule bis hin zum Kopf. Solange die Muskeln rund um das Becken und am Rücken einseitig verhärtet sind, ziehen sich auch frisch gerichtete Wirbel gleich wieder in die alte Position zurück. Lassen Sie sich daher einmal fünf bis zehn Mal hintereinander im Wochentakt massieren, damit die ganze Muskulatur weich wird. Benutzen Sie nach Möglichkeit eine ganzheitliche Massagetherapie (Ayurveda, Thaimassage, Lomi-Lomi oder Shiatsu). Haben Sie sich schon von Ihrem Arzt untersuchen lassen?
Gehen Ihre Beschwerden nicht weg, soll er Sie mal gründlich untersuchen.
Sabine Hurni
Karies verhindern
Ich habe gelesen, dass der Süssstoff Xylit das Karieswachstum bremst und man den Süssstoff auch als Zahnpasta-Ersatz verwenden kann. Was halten Sie von Xylit?
Ursula Antezana, Lenzburg
Es gibt meiner Meinung nach bessere und einfachere Methoden, um Karies vorzubeugen: erstens weniger Zucker essen, zweitens regelmässig die Zähne putzen, drittens nicht ständig etwas essen, sondern dem Speichel Zeit lassen, den Mund zu neutralisieren, viertens täglich am Morgen die Zunge mit einem Zungenschaber abschaben. So können Sie Bakterien aus dem Mund verbannen, ohne dass Sie dem Körper etwas Künstliches zuführen. Xylit enthält zwar keine Kalorien wie normaler Zucker. Der Körper bekommt durch die Einnahme von Xylit jedoch trotzdem die Information, dass nun etwas Süsses folge. Lassen Sie lieber den gesunden Menschenverstand walten im Um-

gang mit Zucker. Das ist die beste Kariesvorsorge. Zudem können Sie auch einen ganz normalen Kaugummi kauen, um Karies vorzubeugen, weil dadurch der Speichelfluss angeregt wird.
Sabine Hurni
Schimmel an Kräutern
Beratung Sabine Hurni
sind, ist das anders. Diese sind strengen hygienischen Regeln unterstellt und haben nur fachgerecht geerntete, getrocknete und gelagerte Kräuter im Sortiment. Gerade aus Gründen der Verunreinigung empfehle ich deshalb den Bezug im Fachgeschäft. Sabine Hurni
Der Weg ins Unbekannte
Ich las kürzlich, dass Depressionen mit einer Therapie und Medikam enten vollständig heilbar ist, wenn man es denn zulasse. Was meinen Sie dazu? Leonhard Zwiauer, Aarau
DR. W. Zürich
Wenn Früchte ein wenig von Schimmelpilzen befallen sind, schneide ich die betroffenen Stellen weg, esse die Früchte aber trotzdem. Ist das schädlich? Und besteht bei Heilkräutern nicht ebenfalls die Gefahr, dass sie von Pilzen befallen sind?
as Thema Schimmelpilze wurde lange verkannt. Es gibt Pilzstämme, die Gift produzieren und so das Krebsrisiko erhöhen können. Nur lässt sich leider nicht abschätzen, ob die Pilze auf der schimmligen Erdbeere nun giftig oder ungiftig sind. Da die Pilzfäden die ganze Frucht durchdringen, nützt das Herausschneiden nicht besonders viel. Das Bundesamt für Gesundheit und die Gesellschaft für Ernährung empfehlen deshalb, entweder wirklich sehr viel davon wegzuschneiden oder das Lebensmittel wegzuwerfen. Ob und wie streng man den Rat befolgt, liegt in der Selbstverantwortung und im Ermessen jedes Einzelnen.
Was die Kräuter betrifft, ist Ihre Vorsicht berechtigt. Wer über das Internet oder über unseriöse Lieferanten Kräuterpillen oder Heilpflanzen bestellt, hat nie die Gewissheit, dass die Pflanzen sauber getrocknet wurden und frei von Schimmelpilzen sind. Bei Kräutern, die bei uns in Drogerien und Apotheken erhältlich
Meine Einschätzung deckt sich grundsätzlich mit dieser Aussage. Es braucht aber unbedingt beides: Die Medikamente helfen dabei, dass die Betroffenen überhaupt die Kraft aufbringen, ihr Leben umzukrempeln. Denn meistens schreit die Depression nach einer Richtungsänderung. Will das Herz das Eine und der Kopf etwas Anderes, kann ein derart grosser innerer Konflikt entstehen, dass man irgendwann völlig blockiert ist und überhaupt nicht mehr aus dem Bett kommt. Der innere Konflikt kann aber auch noch tiefer liegen, auf einer unbewussten, seelischen Ebene.
Der Weg aus der Depression führt meistens zu etwas Neuem, Unbekanntem hin. Dies zu erkennen und auch zuzulassen, braucht wahnsinnig viel Mut. Vielleicht heisst es, etwas aufzugeben, wofür man vorher gelebt hat – einen Glaubenssatz oder einen Wert. Vielleicht muss man ein Gefühl zulassen, das man vorher verdrängt hat, weil es einem zu schmerzhaft erschien.
Wichtig für die inneren Prozesse und als Begleitung auf dem oft steinigen Weg ins Unbekannte ist ein wirklich guter Therapeut, der lösungsorientiert arbeitet. Dabei werden Ressourcen mobilisiert, die den Betroffenen die nötige Energie generieren, um Schritt für Schritt aus dem Loch zu kommen. Sofern sie das wollen. Informationen erhalten Sie auch auf folgenden Webseiten: www.depression.ch oder www.depressionen.ch Sabine Hurni



























!"#$! % ' (!)$!*+, - $.$#*+#/."0!+$01*+# EinneuerWeg,sichleichter,freierundbeweglicherzufühlen! InformationenzurAusbildungoderListederTRAGER-Praktiker
TRAGERVerbandSchweizTVS,Aemättlihof117,6370Stans Telefon0415357177,info@trager.ch,www.trager.ch
EinigeTRAGER-PraktikerInneninIhrerNähe:
Bern: SusanneRoth 0313113257
Einsiedeln: SolangeAckermann 0787418718
Forch-Zürich: MarianneBergerRora 0449181215
Luzern: MonikaHameBuholzer 0788589554
Rafz: NinaHässig-Weber 0787538583
Rheinfelden: SarahRuthBuser 0613319169
Rombach-Aarau: ElisabethBouveratBachmann 0796716084
Rupperswil:MajaK.Richner 0628973012
St.Gallen: DoraMüller 0712442036
Uster: PeterFankhauser 0434978465
Wädenswil: MarianneKellersberger 0447807769
Ayurveda-Pension QuellefürKörper,SeeleundGeist
Ayurveda-Kuren im Le Cocon
Gönnen Sie sich Zeit und lassen Sie sich Ihrer Gesundheit zuliebe verwöhnen. Persönliche, auf Ihre Bedürfnisse abgestimmte Behandlungen und Massagen wirken entschlackend, entspannend und nährend. Johanna Wäfler und Markus Dürst freuen sich auf Sie. Unser Angebot:
•EinwöchigeAyurveda-KurenzumEntschlackenundRegenerieren. •Amrita,dieköniglicheKur.
•Neu: Panchakarma-Kur.
Ayurveda-Pension Le Cocon, rue de la Combe-Grède 33, CH-2613 Villeret Tel. 032 941 61 63, mail@lecocon.ch, www.lecocon.ch
BioHalbpensionPLUSab�422
100%bioim1.BioHotelSüdtirols/Italiens Frühlingszeit-Blütezeit-Kräuterzeit vom17.-24.April2010, mit .WeitereInfosfindenSieauf www.biohotel-panorama.itoderperTelefon00390473831186.

Vom 12.-18.Juli2009 zeigtIhnenNaturarztMarkus Röthlisbergerauffünfmittelschwerenbisleichten Wanderungenbiszu80Heilpflanzenanihrennatürlichen Standorten.Sieerlernendabei,wieKräuterweine, TeemischungenundTinkturenhergestelltwerden.
VomNVSalsWeiterbildung40Stundenanerkannt.
ImPreisvon CHF910.- inbegriffensind: 6ÜbernachtungenmitFrühstücksbuffetund4-Gang-Menü imKurshotel ***WalliserhofinUnterbäch.
MehrInformationenerhaltenSiebei: Hotel***Walliserhof,3944Unterbäch/Wallis Tel.0279342828,Fax0279342829 hotel-walliserhof@oberwallis.ch www.rhone.ch/hotel-walliserhof

Ökologischundzeitgemäss bauenundsanieren.Spart Kosten,schütztdasKlima. ProduktezumDämmenund Dichten.ZumBeispielSchafwolle, Hanf,Kork,Zellulose,Lehmuvm. KontaktierenSieuns,wirberaten Siegerne.


CH–8310Kemptthal Tel.0523451010
CH–1318Pompaples Tel.0218666032 mail@stroba.ch–www.stroba.ch

SchulefürIndividualpsychologie,Familienstellen, Kommunikationssysteme,Beraterpraxis
Lehrgangzumpsych.Kids-undJugendcoachmitZertifikat inRichterswil –Jeweils1Wochenendemonatlich11/2 Jahre
Lehrgangzumpsych.GesundheitsberatermitZertifikat inOltenSO –Jeweils1Samstagmonatlich11/2 Jahre
PETA,dieerfolgreicheSchuleseit1994 DetaillierteKursprogrammeanfordern,AuskunftundAnmeldung: ErwachsenenbildungSchilter LebensarenaPETA Postfach23,6422SteinenSekr.Telefon0448813616 Telefon0418321734 DanielaKeller,8302Kloten wwwlebensarena-peta.chinfo@lebensarena-peta.ch
«Original»Bennybären,braunundweiss ‰ beimEin-undDurchschlafen ‰ inStress-Situationen ‰ beiPrüfungenundProblemen ‰ fürdieGesundheit ‰ weilermitnatürlichen,positiven Schwingungenbehandeltist ‰ waschbarbei30°

NEU:samtweicheWohlfühl-Decken BennyLineSchweiz, Stationsstrasse2,8606Nänikon Telefon0449402746,Fax0449402786 www.bennybaer.ch/E-Mail:bennyline@blumail.ch








SchweizerischerVerbandfürNatürlichesHeilen–ImEinsatzfürdiesanfteMedizin.











Seit über 20 Jahren setzt sich Heinz Knieriemen für «natürlich leben» kritisch mit den Methoden und den Auswirkungen der Schulmedizin und der Laborwissenschaft auseinander Im AT Verlag hat er mehrere Bücher herausgegeben, unter anderem über Vitamine, Mineralien und Spurenelemente oder Inhaltsstoffe in Lebensmitteln und Kosmetika.
Der Garten von Heinz Knieriemen hat wieder reiche Ernte abgeworfen. Daran möchte er Leserinnen und Leser von «natürlich leben» teilhaben lassen.
Mit seinen weissen bis hellblauen Blüten und den filigranen, fein gegliederten Blättern ziert er den Garten – unter anderem auch meinen – und gelegentlich auch Felder und Waldränder: der Schwarzkümmel, im Volksmund auch Jungfer im Grün, Gretel in der Heck, Gretchen im Busch genannt. Heute findet weniger der einst weitverbreitete Acker-Schwarzkümmel (Nigella arvensis) Beachtung, sondern der Echte Schwarzkümmel (Nigella sativa), der auf eine lange Tradition als Heil- und Würzpflanze zurückblickt. Beide gehören zur Familie der Hahnenfussgewächse, sind also nicht mit Kümmel und Kreuzkümmel verwandt.
Der Echte Schwarzkümmel war bis zum 17. Jahrhundert in Europa weitverbreitet. In einem alten Kräuterbuch wird erwähnt, dass die Samen schwarz, sehr ähnlich den Zwiebelsamen und von scharfem, pfeffrigem Geschmack mit süssem Unterton seien. Man brauchte sie für Duftwässer und Puder; gemahlen, in ein Stück Stoff gebunden und erhitzt, regten sie den Ge-
ruchssinn und den Appetit an und vertrieben allerlei Gebrechen.
In Griechenland und der Türkei wird mit Schwarzkümmel noch heute das Brot gewürzt oder er wird als verdauungsfördernde Beigabe fettem Hammelfleisch beigefügt. Die arabische und islamische Volksmedizin nutzt ihn vor allem bei verdorbenem Magen und Koliken, aber auch bei Krämpfen, Asthma, Kopfschmerzen, Parasiten und Würmern. In der indischen Küche ergänzt der Schwarzkümmel als Kalonji ideal Koriander, Nelkenpfeffer, Thymian und Bohnenkraut.
Der Gattungsname Nigella wurde aus dem lateinischen «nigellus» für schwärzlich gebildet und bezieht sich auf die dunklen Samen. Die Kräuterbücher des 16. und 17. Jahrhunderts etwa von Leonhart Fuchs und Lonicerus nennen die Pflanze «Schwartzer Coriander». Die vielfältige und intensive Wirkung des Schwarzkümmels ergibt sich aus der Kombination von ätherischen Ölen und essenziellen, ungesättigten Fettsäuren. Diese stabilisieren die Zellmembranen, können Immunreaktionen wie Allergien unterbinden und stärken die Abwehr bei Pollen- und Staub-

Der Schwarzkümmel, regt Geruchssinn und Appetit an und vertreibt allerlei Gebrechen.
allergikern, Asthmatikern, Akne- und Neurodermitis-Patienten.
Bei uns sind Schwarzkümmelsamen in orientalischen Geschäften als «Black Onion Seeds» erhältlich. Unzerkleinert oder frisch gemahlen können sie ganz einfach verschiedenen Speisen beigefügt werden und eignen sich für Kräuterquark, Salate, Suppen oder Eintöpfe.
Der Acker-Schwarzkümmel war früher auch bei uns vor allem in Auen und Niederungen, etwa im Rhone- und im Rheintal, weitverbreitet. Heute steht er auf der Roten Liste der gefährdeten Pflanzenarten. Nigella arvensis ist durch Intensivkulturen im Getreideanbau (verkürzte Brachzeiten, Häufung der Bearbeitungsgänge, höhere Saatdichte, Herbizide) in seinem Bestand stark zurückgegangen. Wir finden ihn neu gelegentlich in angesäten Buntbrachen, mit denen die Artenvielfalt gefördert wird. In Gärten strahlt er, etwa zusammen mit den orangefarbenen Storchenschnäbeln, einen besonderen Charme aus.
Erinnern Sie sich an meinen letztjährigen Versand von Samen des wilden Fen-
chels? Mehr als 1200 Couverts habe ich nach dem Artikel im «natürlich leben» 4 / 20 09 an interessierte Leserinnen – vor allem diese haben mich angeschrieben –versandt. Den Schwalbenschwanz wirds freuen. Nun sind wieder genügend Fenchelsamen vorhanden, um weitere Wünsche zu erfüllen. Dazu kann ich Ihnen auch Samen des Echten Schwarzkümmels aus meinem Garten anbieten. u
Mit einem an sich selbst adressierten und frankierten Rückantwortcouvert bestellen Sie einige Samen des wilden Fenchels und des Schwarzkümmels aus Heinz Knieriemens Garten, die Sie in einen Aussaattopf oder direkt in den Garten aussähen können. Das Angebot endet am 1. April oder nach dem Erschöpfen des Samenvorrats.
Couvert an folgende Adresse senden: Heinz Knieriemen Dachsweg 12, 4512 Bellach
Richtig gärtnern heisst auch mit Wind und Regen zu arbeiten –nicht gegen diese. Das lehrt einen das Gärtnerleben.
Text Remo Vetter

Der Autor
Remo Vetter wurde 1956 in Basel geboren. 1982 stellte ihn der Heilpflanzenpionier Alfred Vogel ein. Seither ist Vetter im Gesundheitszentrum in Teufen (AR) tätig, wo er mithilfe seiner Familie den Schaukräutergarten von A. Vogel hegt.
Eigentlich lohnt sich das Gärtnern hier oben nicht. Auf über 1000 Metern über Meer sind die Winter lang, kalt und schneereich, der Frühling ist meist nasskalt und die Wachstumsperiode kurz. Kein Wunder, dass Viehzucht und Milchwirtschaft im Appenzellerland dominieren. Aber gerade das hat uns vor 28 Jahren angespornt zu beweisen, dass es auch unter schwierigen Bedingungen möglich ist, erfolgreich zu gärtnern, wenn man mit der Natur und ihren Gesetzen arbeitet. Aus der ursprünglichen Idee ist über die Jahre eine Lebensanschauung und Lebenshaltung geworden.
Weniger ist mehr
Im März ist bei mir die Ungeduld jeweils gross und das Wetter beeinflusst mich jetzt am meisten. Es gibt vor, was heute zu tun ist. Ich beobachte die heranziehenden Wolken. Wird das Wetter halten? Für den biologischen Gärtner ist das ein zentraler Faktor. Meist zieht es mich nach den langen Wintermonaten hinaus, doch schon oft musste ich dafür Tribut zollen. Das Wetter ist ausschlaggebend für meinen Erfolg und damit für das Gelingen meiner Vorsätze. Früher nahm ich mir immer zu viel vor und war dann enttäuscht, wenn ich meine Vorgaben nicht erreichte. Weil der Regen kam, oder sonst etwas Unvorhergesehenes. Heute bin ich gelassener. Ein Trick hilft mir dabei. Abends reflektiere ich den Tag: Was war gut? Was hätte ich besser tun können? Ich versuche, mit mir und meiner Umwelt ins Reine zu kommen. Dann setze ich mir Ziele für den nächsten Tag. Ich tue das bewusst am Vorabend, damit ich am Morgen nach dem Frühstück gleich loslegen kann. Es fällt mir leichter, den Tag so zu beginnen, als
mir frühmorgens den Kopf zu zerbrechen, was ich alles tun könnte.
Weniger ist mehr. Wichtiges ist von Dringendem zu unterscheiden. Fünf Dinge, die ich unbedingt erledigen will, und fünf, die weniger dringend sind, stehen deshalb jeweils auf meiner Gartenliste. Ich habe gelernt, die fünf wichtigen Ziele nicht zu hoch zu stecken und doch so, dass sie ausserhalb meiner Komfortzone liegen. Schliesslich soll es ja eine Herausforderung sein, in gewissem Sinne ein Hinauswachsen über sich selbst.
Für jede schwierige Arbeit beschenke ich mich mit einer schönen Arbeit im Garten oder am Schreibpult. So macht die Arbeit Spass – und das Leben auch. Bei der Arbeit im Garten komme ich dem näher, was ich auch auf Reisen in ländlichen Gegenden immer wieder beobachtet habe: Wenn Menschen mehr Zeit haben, scheinen sie auch glücklicher zu sein.
Das Wetter ist unumstösslich. Es zwingt mich, im Augenblick zu leben. Wer es bekämpft, verschwendet nur seine Zeit. Früher kam es manchmal vor, dass ich trotz Regen oder Schnee im Frühjahr mit Schubkarren, Spaten oder sonstigem schwerem Werkzeug durch den Garten stapfte, dabei den Boden unnötig verdichtete und mir der Lehm wie Leim zentimeterdick an den Stiefeln klebte. Würde ich mich mit meinem heutigen Erfahrungsschatz von der trockenen Stube aus beobachten, ich käme nicht darum herum, über den Spinner da draussen laut zu lachen. Ich habe gelernt, Geduld zu haben, abzuwarten, bis das Wetter stimmt.
Die Erde atmen lassen
Nach dem Regen gehe ich in den Garten und kratze die Gartenbeete durch. Am

Ich habe gelernt, Geduld zu haben, abzuwarten, bis das Wetter stimmt.
liebsten erledige ich diese Arbeit am Morgen. Dann atmet die Erde ein, abends atmet sie aus. Also öffne ich am Morgen mit meiner Kupfer-Pendelhacke die «Kapillaren», lasse die Erde atmen und die Energie fliessen. Die langjährige proaktive Bodenbearbeitung mit der Pendelhacke hat dazu geführt, dass die Gartenerde extrem krümelig und der Boden gut durchlüftet ist. Natürlich beeinflusst die Kombination aus Niederschlag und Wärme das Pflanzengedeihen in unserem
Garten. Doch bin ich überzeugt, dass es unsere Arbeitsweise ist – das Lüften der Erde mit Kupfergeräten –, die Ertrag und Pflanzengesundheit massgeblich verbessert haben.
Jeder Boden hat seine eigenen Gesetzmässigkeiten, die es zu erforschen gilt. Wenn es bei uns tagelang regnet, und das kommt im Frühjahr in unserem voralpinen Klima häufig vor, dann saugt der Boden die Feuchtigkeit wie ein Schwamm auf. Ich muss dann lange abwarten, bis ich die
Bei Remo Vetter können Sie weiterhin BienenweideSamen (Phacelia) bestellen.
Auf offenen Flächen und nicht benutzten Beeten eingesät, bieten PhaceliaPflanzen Bienen gute Lebensbedingungen. Bestellen Sie 50 Gramm biodynamische Samen zum Preis von Fr. 7.50 bei
A Z Fachverlage AG
Redaktion «natürlich leben» Neumattstrasse 1, 5001 Aarau oder unter remo.vetter@natuerlichleben.ch
Wichtige Arbeiten im März
1
B eete vorbereiten
Erst wenn die Sonne den Boden gut erwärmt hat, sollte man an das Vorbereiten der Saat- und Pflanzbeete gehen. Bei uns auf 1000 Meter Höhe warte ich bei den Flachbeeten bis nach den Eisheiligen. Für frühe Aussaaten decke ich die Beete mit Folie ab, damit sich der Boden erwärmt und abtrocknet.
l Mit der Grabgabel den Boden lockern. l Frisch angesetzte Hügelbeete einsäen und bepflanzen.
l Dünger und Kompost ausbringen und einhacken.
2
Aussaaten (ab zweite Hälfte März)
Ich säe gleichzeitig sowohl ins Treibbeet als auch ins Freiland, damit ich ab April laufend mit Gemüse und Kräutern versorgt bin.
l Nochmalige Kontrolle der Saatund Hilfsmittelvorräte. Bei älterem Saatgut allenfalls Keimproben machen, damit unliebsame Überraschungen und Enttäuschungen ausbleiben
l Freiland: Kefen, Knoblauch, Kräuter (bei frostempfindlichen Kräutern wie Basilikum abwarten, bis keine Frostgefahr mehr besteht), Kresse, Pastinaken, Radieschen, Schwarzwurzeln, Spinat, Steckzwiebeln.
l Treibbeet: Kohl, Kohlrabi, Kopfsalat, Kräuter, Kresse, Lauch, Peperoni, Radieschen, Sellerie, Tomaten.
3 B eeren
Rückschnitt, Auslichtungsschnitt, Untersaat mit Bienenweide (Phacelia).
4 O bstbäume
Letzter Termin für Winterschnitt, Baumscheiben mit Laubkompost abdecken und anschliessend Phacelia oder Kapuzinerkresse einsäen.
5 R osen
Rückschnitt der Ramblerrosen, Formschnitt der Buschrosen.
6 K räuter und Blumen
Rückschnitt der mehrjährigen Pflanzen, wenn keine Frostgefahr mehr besteht.
Beete bearbeiten kann, denn zu frühes Bearbeiten verdichtet die Erde. Dafür muss ich meinen Garten ausser bei Neusaaten nie bewässern. Mein Lehrmeister Alfred Vogel hat mich einmal gefragt, wo wohl die gesündesten Pflanzen wüchsen. Dabei zeigte er auf das nahe Alpsteingebirge: «Dort wachsen sie – und wer giesst sie? Niemand ausser der Liebe Gott.» Viele Hobbygärtner fürchten sich vor dem Frost. Für mich ist er eher Helfer als Feind. Natürlich muss ich aufpassen, dass ich die nicht winterharten Pflanzen den Winter hindurch schütze und sie im ungeheizten Glashaus oder in der Orangerie unterbringe. Problematisch wird der Frost für mich im Frühling mit bereits sonnig warmen Tagen und kalten, klaren Nächten. Schon oft sind mir dabei frisch gepflanzte Kürbisse, Zucchini, Gurken oder der Basilikum erfroren. Also doch lieber noch zwei bis drei Wochen abwarten, bis die Eisheiligen vorbei sind. Über die Jahre machte ich wichtige Erfahrungen, inzwischen weiss ich, welche Pflanzen sich für unser Klima eignen.
Vom Winde verweht
Der Wind übt meist einen grossen Einfluss auf unseren Garten aus. Ich muss hauptsächlich auf zwei Winde achten. Von Süden kommt der warme Föhnwind, ähnlich dem

Mistral in Frankreich. Er bläst stark, trocknet den Boden aus und knickt manchmal Bäume und Sträucher wie Zündhölzer. Von Westen kommen im Frühling die meist langanhaltenden Regenperioden, oft von Sturmwinden begleitet. Als Schutzmassnahmen pflanzte ich ansteigende Hecken. Sie leiten die Winde nach oben und über den Garten hinweg ab. Die natürliche Massnahme hat sich bewährt. Versuche mit Mauern bremsten zwar den Wind ab, schützten aber nur die im Windschatten liegende Fläche.

In unserem terrassierten Garten stehen deshalb überall Hecken als Windbrecher. Diese müssen nicht sehr hoch sein. Vor allem einheimische Gehölze eignen sich gut. Bewährt haben sich an unserer Hanglage Haselnuss und Weide. Sie wachsen schnell, bilden ein gutes Wurzelwerk und lassen sich zu Hecken flechten. Auch Gartenpflanzen wie Topinambur, Stangenbohnen oder Beerensträucher leisten als Windbrecher wertvolle Dienste. Die mehrjährigen Kräuterbeete fasse ich mit Buchsbaum und Lavendel ein.
Der Wind ist aber nicht nur ein Ärgernis. Der warme Föhn trocknet die Beete nach anhaltenden Regenfällen schnell wieder ab, und der Westwind bläst mir den Garten und die Landschaft sauber. Das Alpsteinmassiv erscheint nach einem Regenguss zum Greifen nahe. u





































Internet _Der Baum des Lebens
Im Lauf von rund vier Milliarden Jahren schuf die Evolution einen vielfältig verzweigten Baum des Lebens. Diesen Stammbaum der Arten und deren Verwandtschaftsbeziehungen untereinander darzustellen, ist das Ziel des Internetprojekts Tree of Life Web. Hunderte von Biologen –darunter auch Schweizer Wissenschaftler – und Naturfreunden tragen ihr Wissen in Form von Forschungsresultaten, Artbeschreibungen und Bildern zu einem möglichst vollständigen Bild des Lebens und der Artenvielfalt zusammen. Von heute noch existierenden und ausgestorbenen Lebewesen, von den Anfängen des Lebens bis zur Gegenwart, von den Archaebakterien bis zum Menschen zeigt dieser Lebensbaum, «wie alles zusammenhängt» und liefert ein Abbild der überwältigenden Artenvielfalt unseres Planeten.
Das Non-Profit-Projekt wird von der U.S. National Science Foundation und der University of Arizona finanziell unterstützt. ajo _ www.tolweb.org
Im Gefolge der Menschen haben die Spatzen unaufhaltsam die Welt erobert. Doch in den letzten Jahren ist der Allerweltsvogel vielerorts seltener geworden.
Text Heini Hofmann

Wohl kaum ein anderes, frei lebendes Lebewesen dieser Erde folgte dem Menschen derart intensiv auf Schritt und Tritt: auf den Bauernhof und in die Grossstadt, ins Landesinnere hinein, zu den Meeresküsten hinab und bis gegen 3000 Meter Höhe hinauf, in südliche Breiten und über den Polarkreis hinaus – kurz überall hin, wo es noch menschliche Siedlungen gibt. Heimlich hat ein kleiner, sich plusternder, andauernd schwatzender, ständig streitender, nervös
hüpfender, extrem geselliger, aber bloss unscheinbar aussehender Vogel sozusagen die ganze Erde zu seiner ökologischen Nische erklärt. Die Rede ist vom Spatz. Solch phänomenaler Verbreitungsdrang und eine unerhörte Anpassungsfähigkeit machten den quirligen Federball schliesslich zur häufigsten Vogelart in unmittelbarer Nähe des Menschen. Und all das ohne behördlichen Gesetzesschutz, sondern vielmehr unter dem Druck ständiger Verfolgung und Bekämpfung. In den
letzten Jahren haben die Bestände in Europa jedoch teilweise stark abgenommen, sodass Vogelschützer teilweise bereits Alarm schlagen (siehe Kasten Seite 41).
Souvenir aus der Heimat Ursprünglich war der Sperling im Mittelmeerraum zu Hause. Dann verschleppten ihn europäische Auswanderer rund um den Erdball, teils aus sentimentalen Gründen, indem sie in ihm eine Handvoll lebendige Heimat sahen, teils aber auch im
damaligen Irrglauben, mit ihm einen tüchtigen Helfer für die Schädlingsbekämpfung in der Landwirtschaft mitzuführen.
Während anfänglich eigens dafür gegründete private Gesellschaften sich um das Aussetzen der Vögel bemühten, mussten bereits wenige Jahrzehnte später die Geister, die man unüberlegt gerufen hatte, energisch bekämpft werden. Denn die Spatzen richteten im Getreidebau erhebliche Schäden an.
Der Flug des Sperlings rund um die Welt hört sich an wie ein Märchen. Ein erster Aussetzungsversuch in New York mit acht Pärchen im Jahre 1850 misslang. Dafür war das Freilassen von 50 Spatzen ein Jahr später umso erfolgreicher. Weitere Aussetzungen in Nordamerika folgten. Nach einem knappen Menschenleben wimmelte die Neue Welt von Spatzen. 1872 erfolgte der erste Ansiedlungsversuch in Buenos Aires, gefolgt von Brasilien, Chile und Uruguay. In der zweiten Hälfte des 19. Jahrhunderts schlug die Stunde des Spatzes auch in Australien und Neuseeland. Etwas weniger rasant war seine Ausbreitung in Südafrika, da sich hier die Konkurrenz verwandter Vogelarten bemerkbar machte.
So gelang es dem ausgeprägt anpassungsfähigen Vogel in wenigen Jahrzehnten, ganze Kontinente zu besiedeln. Sein weltumspannendes Verbreitungsgebiet weist heute deshalb kaum mehr weisse Flecken auf.
So wie der Mensch den Sperling überallhin mitnahm, so scheint der Vogel auch die menschliche Gesellschaft zu suchen. Überall dort in Europa, wo Menschen festen Wohnsitz haben – bis in den hohen Norden und bis in hochgelegene Bergtäler – trifft man den als Kulturfolger veranlagten, quecksilbrigen Vogel an.
Sein Hauptverbreitungsgebiet in Europa sind jene Landstriche, wo menschliche Siedlungen liegen und wo Ackerbau betrieben wird. Einen sprechenden Beweis für das Vorhandensein einer gewissen Abhängigkeit des Spatzen vom Menschen liefert die Tatsache, dass zwischen Einwohnerzahl der Menschen und Bestandesdichte der Spatzen eine Relation besteht.
Wo die einen sind, da lassen sich meist auch die andern nieder.
Verfolgter Schädling
Eigentlich ist der Spatz mehrheitlich Vegetarier und ernährt sich in erster Linie von Sämereien, wobei er eine besondere Vorliebe für Getreide entwickelt hat. Am liebsten mag er Weizen und Hafer. Ganz besonders schmecken ihm die weichen, milchreifen Körner. Deshalb haben ihn die

Bauern stets als Schädling verfolgt – total erfolglos.
Der kleine Tausendsassa wusste seinen Kopf immer wieder aus der Schlinge zu ziehen. Seine Ausbreitung über die Kontinente hat nachgewiesenermassen oft gerade entlang der Getreidetransportwege stattgefunden. Dabei liess er sich von Getreideschleppkähnen und Güterwagen oft über weite Distanzen dahintragen. Auch unsere Alpentäler besiedelten sie schritt
In Mitteleuropa sind die Bestände des Haussperlings vor allem in Städten zurückgegangen. Dafür verantwortlich könnte die moderne Bauweise sein.
Obwohl der Hausspatz immer noch als omnipräsenter Allerweltsvogel wahrgenommen wird, nehmen seine Bestände in Europa vielerorts ab. So verschwanden allein in London innert weniger Jahre 60 Prozent der Haussperlinge. In Hamburg nahmen die Bestände in den 1990erJahren sogar um 75 Prozent ab. Rund um den Bodensee sank die Zahl der Brutpaare seit 1980 um 40 Prozent.
«Im Vergleich zum Ausland fällt der Rückgang des Hausspatzes in der Schweiz bislang weniger deutlich aus», sagt Matthias Kestenholz von der Schweizerischen Vogelwarte Sempach. Doch eine generelle Einschätzung sei schwierig, da an vielen Orten keine Langzeitdaten vorhanden seien, erklärt der Ornithologe.
Genaue Erhebungen liefert der aktuelle Zürcher Vogelatlas. Demnach san

ken die Bestände im Kanton Zürich von 1988 bis 2008 um über 20 Prozent. «Es lässt sich vor allem ein deutliches StadtLandGefälle erkennen», so Kestenholz. «In der Stadt registrieren wir in der Regel stärkere Rückgänge als auf dem Land.» Als Hauptursache dafür sieht der Vogelexperte die urbane Bauweise. Moderne oder sanierte Gebäude hätten meist glatte Fassaden ohne Nischen. «Damit gehen in der Stadt wichtige Brutplätze verloren», sagt er. Gewisse Fachleute vermu
ten laut Kestenholz zudem, dass eine höhere Schadstoffbelastung und Mangelernährung für die Rückgänge in städtischen Gebieten verantwortlich sein könnten.
Einzelne Experten gehen davon aus, dass es sich bei den Bestandesschwankungen der Spatzen bloss um natürliche Fluktuationen handelt. «Dass die negativen Entwicklungen über relativ grosse Zeiträume verlaufen, spricht gegen natürliche Schwankungen», sagt hingegen Kestenholz. ajo

!"#$%&$'()*+, "$-.'+/+%"#0+%1%
.)2'3*+"2+$45/+6( !"#$%&'()!)*!"+!,-.& /012&344.564*7088.5&948&#: ;&#&3ž#-<&=>.?5&1@3 ;&#A39#;52A5&-3>@3& 7$*'+/#%+3$&$#"* -&2"$&$-0+6(80&+$&$ B183&158=015<3C>.6<393470<93131 D0431@&36'34*E"!F)G(!HII!)!) 9:;<=>7?@>=.7;>?;7AB?@ =1J0K&04=>&6>=516A#>. LLL#&04=>&6>=516A#>.M4NAO04=6A

Körperzentrierte/r

StudiumgemässEMR-Richtlinien mitdenFachrichtungen: •KlassischeHomöopathie
•ChinesischeMedizin
•EuropäischeNaturheilkunde
Studienbeginn:August2010
Eulerstrasse55,4051Basel
Tel.0615603060,www.anhk.ch
„DasLebenist,
waswirselbst darausmachen.“ Dr.med.YvonneMaurer
Berufsbegleitende, anerkannteWeiterbildungen mitDiplomabschluss:
GRATIS-InfoAbend:21.4.10
Psychologische/rBerater/inIKP PsychologieundKörpertherapie
Ernährungs-
ACADEMY OF CHINESE HEALING ARTS
Berufsbegleitende und Vollzeitausbildung in:
� Akupunktur
� Kräuterheilkunde
� Tui Na/An Mo Massage
� Diätetik
� Qi Gong
� Medizinische Grundlagenfächer
Academy of Chinese Healing Arts
Unterer Graben 1 | 8400 Winterthur
Telefon 052 365 35 43 info@chiway.ch | www.chiway.ch
GRATIS-InfoAbend:3.3.10
Psychologische/rBerater/inIKP PsychologieundErnährungsfachwissen
Paar-&Familientherapeut/inIKP SystemischesCoaching Komplementäre/r Atemtherapeut/inIKP Atem-undBewegungstherapie
GRATIS-InfoAbend:16.4.10
GRATIS-InfoAbend:20.4.10
AusbildungsinstitutfürGanzheitlicheTherapienIKP,inZürichundBern.
MehrInfos?
Tel. 0442422930 www.ikp-therapien.com
Seit25Jahrenanerkannt
SABINE HURNI dipl.Naturheilpraktikerin
SABINE HURNI dipl.Naturheilpraktikerin
SABINE HURNI dipl.Naturheilpraktikerin
Bruggerstrasse 37
Bruggerstrasse 37
Bruggerstrasse 37 5400 Baden
5400 Baden
5400 Baden
056 209 12 41
056 209 12 41
056 209 12 41
079 750 49 66 info@shurni.ch www.shurni.ch
079 750 49 66 info@shurni.ch www.shurni.ch
079 750 49 66 info@shurni.ch www.shurni.ch
InstitutfürKlang-Massage-Therapie ElisabethDierlich
PeterHessAkademieSchweiz

DerinnovativsteZapperaufdemMarkt DerVariZapper

Ausbildunginder PeterHess-Klangmassage

Weiterbildungin


KlangtherapieElisabethDierlich
VertriebvonPeterHessproducts® Qualitätsklangschalen·GongsundZubehör
WirsendenIhnengerneunseraktuellesProgrammzu.


InstitutfürKlang-Massage-Therapie ElisabethDierlich
Oberdorf8·5040Schöftland/AG
Tel:0041-628920558
Fax:0041-628920562 kontakt@klang-massage-therapie.ch www.klang-massage-therapie.ch www.peter-hess-akademie.ch

ESSEN.TRINKEN. SCHLAFEN. MANGER.BOIRE. DORMIR. LINDENEGG5 CH-2502BIEL/BIENNE TEL.0323229466 www.lindenegg.ch
Dr.HuldaClarksZapper wurdesehrbekanntin denletztenJahrenundisteinfesterBestandteil ihresProtokollsgeworden.Der VariZapper istdienächsteEvolutionIhresZappers. DasKennzeichendesGerätsistseinemodulare Konstruktion: DeruntereTeildesGerätskannherausgenommenwerdenunddurchden VariGamma Frequenzgeneratorersetztwerden,umdasGerät ineinenvollständigenBio-Frequenzgeneratorfür komplexereAnwendungenumzuwandeln.Der VariZapper kanndeshalbineinenFrequenzgenerator (aucheinzelnerhältlich)füreinenBruchteilderKosten umgewandeltwerden.
Daskomplexere VariGamma Systemwurde aufeineintuitiveArtentwickelt,umeineinfaches Programmierenzuermöglichen.Wenneinindividuelles programmierendes VariZappers erwünschtist, könnenkleineKärtchen,besserbekanntals Program DriverCards(PDC’s) eingesetztwerden.DieProgram DriverCardsenthaltenReihenfolgenvongezielten FrequenzengemässDr.HuldaClark’sFrequenzliste. www.drclark.com
DieNr1.WebseitefürProduktenachDr.HuldaClark Dr.ClarkZentrum,Zieglerstrasse44,CH-3007Bern Tel+41318683131Fax+41318683132info@drclark.com
BISTROT: DI–SA/MA–SA17–23.30h SO/DI10–18h MONTAGGESCHLOSSEN FERMÉLELUNDI

Hausspatz ohne und rechts der Feldspatz mit Wangentupf.

Zur Sommerzeit und im Herbst beliebt ihm süsses und saftiges Obst: Kirschen, Bir nen und Weinbeeren.
weise zusammen mit dem im letzten Jahrhundert dort vordringenden Ackerbau.
Trotz intensiver Verfolgung des Sperlings seit dem Mittelalter, war die Lawine seiner Ausbreitung nicht aufzuhalten. In früheren Jahrhunderten waren die Bauern vielerorts durch obrigkeitliche Verordnungen gehalten, jährlich eine bestimmte Anzahl Spatzen zu vernichten. Die Säumigen wurden mit saftigen Bussen bestraft. Später folgten Massenvernichtungen mit Gift; doch das Stehaufmännchen Spatz fuhr unbeirrbar fort, sich zu vermehren und zu verbreiten.
Auf des Sperlings Speisezettel steht aber nicht bloss Getreide. Besonders im Frühjahr tut er sich gütlich an Knospen und zarten Setzlingen, pickt unreife Erbsen aus den Schoten und macht sich sogar hinter die gelb leuchtenden Krokusblüten und Primeln. Zur Sommerzeit und im Herbst beliebt ihm süsses und saftiges Obst: Kirschen, Birnen und Weinbeeren.
Kurzes Spatzenleben
Doch es wäre ungerecht, den Spatz bloss als Getreide und Obstdieb hinzustellen. Er vertilgt natürlich auch Insekten und andere Kerbtiere. Der Feldsperling mehr noch wie der Hausspatz. Bei beiden stellen Heuschrecken, Käfer und Schmetterlingslarven sogar den Hauptbestandteil des Futters für die Jungen dar. Selbst Insekten im Flug werden vom Sperling geschickt abgefangen.
Im Winter brauchen die kleinen Federbälle wegen des hohen Wärmeverlustes kalorienmässig einen Drittel mehr Futter. Das bedeutet, dass sie bei fast halb so langer Tageslichtdauer und weniger Nahrungsangebot mehr aufnehmen müssen. Wer nicht kräftig ist, übersteht diesen Stress nicht. Das ist das grausam harte, aber gesunde Auswahlverfahren der
Natur. Dafür bleibt dann in der warmen Jahreszeit mehr Zeit für Liebesleben oder Balz, für das Fortpflanzungsgeschäft, Nestbau und Aufzucht der Jungen, dieTerritoriumsverteidigung, aber auch fürs gesellige Leben in der Kolonie und für die Gefiederpflege, das heisst Sand und Wasserbadplausch.
Die hohe Zeit der Spatzenhochzeit ist der Herbst. Da balzen die Männchen mit hängenden Flügeln und gestelztem Schwanz vor ihren Auserwählten und tschilpen und lärmen dabei in den höchsten Tönen. Mit Einbruch des Winters flaut die Balz ab und beginnt zu Beginn der Brutzeit im Februar von Neuem.
Nachdem es schon nur 50 Prozent aller Jungspatzen zum Ausfliegen bringen, stirbt von diesen nochmals die Hälfte bereits in den zwei ersten Lebensmonaten. Und nur 20 Prozent überleben ein volles Jahr. Mehr noch: So ein Spatzenleben dauert in der freien Natur im Schnitt kaum mehr als ein Jahr. Neben Krankheiten und Parasiten lauern den Sperlingen mancherlei Gefahren: der Mensch, der Verkehr (Spatzen sind diejenige Vogelart mit den meisten Verkehrstoten), Giftweizen, aber auch Katzen, Sperber und Eulen.
Doch trotz des harten und kurzen Lebens hat es der Spatz verstanden, sich der menschlichen Zivilisation ständig anzupassen. Er nistet unter unseren Hausdächern, er lebt von unserem Acker und Gartenbau und unseren Abfällen und er entdeckt immer wieder neue Nahrungsquellen, wie zum Beispiel das kräftesparende Fressen angesammelter, toter Insekten ab den Kühlergittern geparkter Autos. Oder er schafft es, in einer tristen Bahnhofhalle zu überleben. u
Sein Name, Sperling oder Spatz, stammt ab vom althochdeutschen «spar» oder «sparo», was zappeln bedeutet und wohl seine hüpfende Fortbewegungsart charakterisieren soll. Der Schweizer Naturforscher Conrad Gesner nannte ihn im 16. Jahrhundert in seinem Werk über die Vögel den Husspar.
Die beiden hierzulande hauptsächlich vorkommenden Sperlinge sind der Hausspatz und der Feldspatz. Der Letztere lebt, wie schon sein Name sagt, mehr am Rand der Ortschaften, in Gärten, Feldern und am Waldrand. Der Hausspatz dagegen folgt dem Menschen in die Siedlungen und bis mitten in städtische Agglomerationen. Ihm begegnen wir vor allem.
Das typischste Unterscheidungsmerkmal beim etwas kleineren Feldsperling ist der dunkle Wangentupf, schwarz beim Männchen respektive braun beim Weibchen, der beim Haussperling fehlt.
Hüpfen statt fliegen
Der in Südbünden vorkommende Italienspatz sieht dem Hausspatz ähnlich; das Männchen jedoch weist anstelle eines aschgrauen einen kastanienbraunen Scheitel auf, helle Wangen und eine ausgedehnt schwarze Kehle und Brust. Die Weibchen dagegen sind schwierig zu unterscheiden. Der in alpinen Regionen lebende Schneefink, den die Wissenschaft vor einigen Jahren auf Schneespatz umgetauft hat, ist grösser und kräftiger, mit grauem Kopf, braunem Rücken, heller Unterseite und einem aussen weissen Schwanz. Die Männchen haben eine schwarze Kehle, die Weibchen sind matter gefärbt.
Im Gegensatz zu den mehr fliegenden Vogelarten sind Spatzen ausgesprochene «Hüpflinge», die sich ständig nach sicherer Deckung Ausschau haltend kaum in offenes Gelände trauen. Spatzen sind zudem typische Standvögel. Ihr Leben spielt sich meist im Umkreis von bloss einem Kilometer ab. Etwas mehr Ausbreitungstendenz zeigen die Jungvögel, die sich in Entfernungen bis zu 30 Kilometern häuslich niederlassen.


Ungerührt geleitet die Entenmutter ihren Nachwuchs durchs dicht stehende Schilf ans freie Wasser. Dass sie dabei von einer ganzen Kinderschar beobachtet wird, stört sie überhaupt nicht. Die Kinder lehnen sich über das Geländer einer kleinen Holzbrücke im Naturschutzgebiet Etang de la Gruère im Jura. Der Mensch als faszinierter, teilnehmender Beobachter: So soll es sein in diesem Kleinod inmitten der von Weiden, Wald und stattlichen Gehöften geprägten jurassischen Landschaft auf 1000 Metern über Meer.
Trittspuren am Ufer und im Wald zeigen indes, dass es viele Besucher mit dem strikten Weggebot nicht allzu genau nehmen. Sie stören dabei nicht nur die Wildtiere, sondern machen auch dem empfindlichen Boden zu schaffen. Dabei befinden sie sich in einem Schutzgebiet, das schon 1943 eingerichtet wurde, um eine der schönsten Moorlandschaften der Schweiz vor der endgültigen Zerstörung zu bewahren.
Eine Mondlandschaft
Es war eine Pioniertat des Naturschutzes. Als andernorts in der Schweiz noch grossflächig Torf gestochen wurde, kam es hier zur endgültigen Einstellung des Torfabbaus. Seither darf das Moorgebiet des Etang de la Gruère auch nicht mehr entwässert werden. Um an den Torf heranzukommen, wurde das Wasser der nassen Böden seinerzeit mit tiefen Gräben aus dem Moor geleitet. Danach entfernte man die Pflanzendecke. Der Torf selbst wurde mit grossen Messern in backsteingrosse Stücke zerschnitten und zu kleinen Pyramiden aufgestapelt. Damals sah es hier aus wie in einem Braunkohlerevier nach Einstellung des Tagbaus – eine Mondlandschaft, geprägt vom braunschwarzen Torf. An einigen Stellen ist das Moor heute so trocken geworden, dass nun Tier und Pflanzenarten gedeihen, die die feuchten Moorbedingungen nicht ertragen. Das sind etwa die rund um den Moorteich häufigen, sich meist kümmerlich entwickelnden Fichten. Sie sind erst nach Einstellung des Torfabbaus aufgekommen. Der heutige Fichtenwald soll nur eine Zeit des Übergangs sein. Denn seit den 1980erJahren wird die Regeneration des Etang de la Gruère auch aktiv betrieben. Seither sind auf rund vier Hektaren die Entwässerungsrinnen zugeschüttet worden, sodass
sich das Moor langsam wieder mit Wasser füllt und die Böden vernässen. Den Bäumen behagt dies gar nicht, sie werden im Laufe der Jahre nach und nach absterben und von wurzellosen SphagnumMoosen überwuchert, die wiederum die Torfbildung in Gang bringen werden.
Danach könnte es hier wieder so aussehen wie in den vom Torfabbau unberührten Flächen: Die Böden fühlen sich schwammig an, die Bewaldung ist nur sehr spärlich. Solche Landschaften kennt man aus Kanada oder Finnland, in der Schweiz sind sie selten und entsprechend schutzwürdig.
Die Geschichte des Etang de la Gruère beginnt vor Jahrmillionen, als während der letzten Jurafaltung der Doubs ein immer tiefer werdendes Flussbett grub. Dies liess auf dem Hochplateau der Freiberge den Grundwasserspiegel allmählich absinken, was Platz schuf für ein Flüsschen, das sich bei La Gruère ein Bett in den weichen Kalkfelsen grub. Es dauerte Jahrtausende, bis das Gewässer eine weitgehend wasserdichte Mergelschicht freigelegt hatte, auf die sich während der Eiszeiten dicke Eispanzer legten. Nach deren Abschmelzen staute sich in dieser Senke das Wasser.
Vor etwa 12 000 Jahren gediehen im Gebiet der heutigen Halbinsel die ersten Rohrkolben und Binsen. Später kamen Blumenbinsen und Schlammseggen dazu, die alle mit wenig Nährstoffen auskommen. Rund ein Jahrtausend später bildeten sich die für Hochmoore typischen Torfmoose. Diese Pflänzchen überwucherten die anderen Pflanzen und begannen, auf der kalkarmen Mergelschicht das Hochmoor aufzubauen. Seine maximale Ausdehnung erreichte dieses vor 7000 Jahren. Seither wächst es nur noch in die Höhe. Heute ist die Torfschicht am Etang de la Gruère bis zu acht Meter dick.
Jahrhundertelang blieb die Moorlandschaft vom Menschen weitgehend unberührt. Das änderte sich im Jahr 1650, als am Ausgang der Talmulde eine Mühle gebaut wurde mit Reservoir und Schleuse zur Wasserregulierung. Am tiefsten Punkt des Moores wurde dazu ein Staudamm aufgeschüttet. Dieser Damm hat das Moor nachhaltig verändert. Grosse Teile versanken im Stausee.
Rund 300 Jahre drehten sich die Wasserräder. Erst im Jahr 1952 wurde in der lo

Die Moorlandschaft in Zahlen
Die gesamte Moorlandschaft von La Gruère umfasst 210 Hektaren. Davon sind 11 Hektaren Flachmoore, 56,5 Hektaren Hoch- und Übergangsmoore. Der Moorsee hat eine Fläche von 8 Hektaren. Das eigentliche Naturschutzgebiet ist 120 Hektaren gross. Über 500 Pflanzen- und Tierarten leben in La Gruère, unter ihnen: 17 Seggen, 35 Pilze, 32 Moose, 118 höhere Pflanzen, 109 Spinnen, 32 Wasserkäfer, 24 Libellen, 22 Schmetterlinge, 12 Heuschrecken, 6 Fische, 8 Amphibien, 65 Brutvögel und 20 Säugetiere. 60 dieser Arten sind in der Schweiz bedroht.
Sehr empfehlenswert ist ein Besuch des Zentrums für Forschung, Information und Moorschutz am Rande des Moorgebietes. Neben einer Dauerausstellung und einem Naturlehrpfad sind auch Führungen durch das Moor im Angebot. Das Naturschutzzentrum Les Cerlatez ist von Ostern bis Ende Oktober für das Publikum geöffnet.
Stiftung Les Cerlatez
Case Postale 212, 2350 Saignelégier Telefon 032 951 12 69 www.centre-cerlatez.ch

25_AT_Naturparadies_EtangGruere

















Die Schweizer sind ein Volk von Rasern. Die Rede ist nicht vom Strassenverkehr, sonder n vom Umgang mit der Zeit. Kein anderes Volk auf der Welt ist so effizient, so schnell unterwegs. Text Martin Arnold

Die Schweizer rasen durch die Zeit. Zu diesem Schluss kam der amerikanische Psychologe Robert Levine schon vor zehn Jahren und bis heute hat sich daran nichts geändert. Er schreibt in seinem Buch «Eine Landkarte der Zeit» über die Schweiz: «Ihr wurde die Ehre des ersten Platzes zuteil, weil sie in allen Bereichen auf hohen Rängen landete.» Die Schweizer im Temporausch. Das Stakkato der Atemlosigkeit hallt nach, wenn der deutsche Zeitforscher Karlheinz Geissler den durchschnittlichen Tagesablauf eines Deutschen (oder Schweizers) als Kanon der Moderne repetiert: Weckerklingeln, Dusche, Nachrichten, ein schneller Kaffee, Zähneputzen, Ärger über die Verspätung von Bus und Zug, Uhrenvergleich im Büro, Beschwerde wegen Zeitdruck, Besprechung über Effizienzsteigerung und so weiter und so fort. Es scheint fast, als sitzen wir in einem Auto, das immer schneller fährt und gleichzeitig immer langsamer vorwärtskommt: Verdichtung, Vergleichzeitigung, Multitasking sind Attribute, ohne die ein moderner urbaner Mensch scheinbar nicht mehr bestehen kann. Jede Stunde steht unter Zeitdruck: Sie muss online, mit Handy, Radio, Fernsehen oder im Home Office genutzt werden. Das Gefühl für Geschwindigkeiten geht verloren. Während Johann Wolfgang von Goethe noch fast einen Monat brauchte, um nach Italien zu kommen, können wir heute virtuell mit der Web-Cam die Distanz in Echtzeit überwinden und jederzeit im Internet schauen, wie es gerade jetzt im Hafen von Palermo aussieht.
In über zehn Jahren Recherchearbeit ging Levine der Frage nach, in welchen Kulturen das Tempo besonders schnell und in welchen besonders langsam ist. Dabei wurde ein Umstand offensichtlich: Eile haben scheint eine Veranlagung der Europäer zu sein. Denn ausser Japan und Hongkong schaffte es kein aussereuropäisches Land in die Top Ten.
Levine verglich in 31 Ländern verschiedene Zeitindikatoren. Freilich sind Alltagssituationen, aus denen er Aufschluss
auf das Lebenstempo einer Gesellschaft zieht, etwas willkürlich gewählt. Aussagekräftig sind sie dennoch. Ein Indikator ist die Gehgeschwindigkeit, die ein Fussgänger in einer Innenstadt innerhalb von 20 Metern hinlegt, andere Indikatoren sind die durchschnittliche Wartezeit bei der Post und die Genauigkeit der öffentlichen Uhren. Über die Schweizer Uhren schreibt Levine: «Sie liefern ein höllisch gutes Resultat.»
Bei der Gehgeschwindigkeit landete die Schweiz hinter Irland und den Niederlanden auf Platz drei und bei der Bedienung am Postschalter hinter Deutschland auf Platz zwei. Im Ländervergleich landet Irland auf Platz zwei, Deutschland auf Platz drei, gefolgt von Japan, Italien, England, Schweden und Österreich. Acht der neun getesteten europäischen Länder lan-

Nonstop –eine Ausstellung über die Geschwindigkeit des Lebens Wir sind schnell unterwegs. Und dies nonstop, rund um die Uhr. Wir sparen permanent Zeit und haben doch immer zu wenig davon. Das Stapferhaus Lenzburg beleuchtet mit der Ausstellung «nonstop» das temporeiche Leben. Es inszeniert im Zeughausareal in Lenzburg eine Time-out-Zone, in der es die Besucher in eine Welt von Tempomachern und Tempotherapeuten führt, zwischen Blackberrys und Yogamatten, Expresskassen und Wellness-Oasen. Die Ausstellung zeigt, wie wir zu Kindern der Zeit geworden sind und fragt danach, wie wir mit dem Tempo Schritt halten. Die Ausstellung dauert bis Ende Juni 2010.
_ www.nonstop.stapferhaus.ch






























Am Amazonas gewannen die Indios einst fruchtbares Land, indem sie Kohle in die Böden mischten. Heute erhofft man sich davon neuen Segen. Biokohle soll gute Ernten garantieren und Treibhausgase vermindern – auch hierzulande.
Text Beatrix Mühlethaler
Der Biokohle ist es zu verdanken, dass die Fruchtbarkeit der genutzten Urwaldböden über Jahrhunderte erhalten blieb.
Der Amazonas-Regenwald wurzelt, auch wenn er noch so üppig gedeiht, in verwittertem, saurem Boden. Brandgerodete Flächen sind folglich nur kurze Zeit frucht- und damit nutzbar. Gross war deshalb das Erstaunen, als man im letzten Jahrhundert bei Ausgrabungen im brasilianischen Urwald vorkolumbianische Städte entdeckte. Dass es hier eine blühende Zivilisation gab, wie es ein spanischer Kundschafter im 16. Jahrhundert beschrieb, hielt man vor diesen Funden für eine Legende. Wie hätte sich denn eine sesshafte Bevölkerung auf dem unfruchtbaren Urwaldboden ernähren können?
Die Antwort fanden Forscher, als sie im Umfeld der versunkenen Städte auf tiefgründige schwarze Böden stiessen. Diese – nach dem portugiesischen Wort für schwarz – als Terra Preta bezeichnete Erde erwies sich als äusserst fruchtbar.
Analysen brachten den deutschen Bodenkundler Bruno Glaser in den 1990erJahren auf die Spur, wie diese nährstoffreichen Böden entstanden sein müssen: Die Indios reicherten die unfruchtbaren Tropenböden offenbar mit allerlei organischen Abfallstoffen an, die pflanzlichen, tierischen und menschlichen Ursprungs waren. Ein Teil dieser Biomasse bestand aus verkohltem Material ähnlich der Holzkohle, die durch Verschwelen in Kohlemeilern oder an Lagerfeuern entsteht.
Alte Methode neu entdeckt
Dieser sogenannten Biokohle ist es zu verdanken, dass die Fruchtbarkeit der genutzten Urwaldböden über Jahrhunderte erhalten blieb. Denn die in den Boden eingebrachte Kohle verband sich mit den ursprünglichen Schluff- und Tonteilchen zu einer tiefschwarzen Erde, die von Bodenorganismen kaum abgebaut wird. Die Nährstoffe sind darin so stark eingebunden, dass Regen sie nicht auszuwaschen vermag. Terra Preta speichert auch Regenwasser überdurchschnittlich gut und für das Gedeihen von Kulturpflanzen liegt der

pH-Wert im optimalen neutralen Bereich. All das zeigten Feldversuche von Bodenkundlern. Garten- und Landwirtschaftsratgeber aus dem 19. Jahrhundert dokumentieren, dass man die Vorteile von Biokohle einst auch in unseren Breitengraden kannte und nutzte.
Kein Wunder, dass das alte Verfahren heute neue Wertschätzung gewinnt. Degradierte Böden sollen damit nachhaltig wieder fruchtbar gemacht werden. Laut Fachleuten liessen sich auch die Lebensmittelerträge weltweit besser sichern.
Neue Methoden erlauben es zudem, Biokohle auf zeitgemässe Art herzustellen. Im sogenannten Pyrolyseverfahren
wird in einem Tank getrocknete Biomasse aus Stroh, Grüngut oder Mist ohne Sauerstoffzufuhr auf Temperaturen von 400 bis 800 Grad Celsius erhitzt. Dabei entsteht einerseits reine Kohle, andererseits ein Gas, das flammenlos oxidiert wird. Eine solche Anlage liefert auch Energie in Form von Strom und Wärme. Allerdings ist die Ausbeute geringer als bei konventionellen Biogasanlagen.
Klimaschutz mit Biokohle
Der agronomische Nutzen allein erklärt aber nicht, warum heute das Interesse an der Biokohle neu erwacht. Eine wachsende Anhängerschaft attestiert ihr zusätzlich grosses Potenzial im Kampf gegen den Klimawandel. Pflanzen nehmen im Laufe ihres Lebens aus der Luft CO2 auf und binden es. Während dieses Treibhausgas wieder frei wird, wenn Pflanzen verrotten oder verbrennen, bleibt ein grosser Teil des Kohlenstoffs beim Verkohlen im Restmaterial gebunden. Arbeitet man Biokohle in den Boden ein, bindet man damit auch Kohlenstoff und entlastet die Atmosphäre. Solche Böden könnten als zusätzliche CO2-Senken dienen.
Eine andere Methode zur CO2-Speicherung wird heute breit diskutiert: Bei neuen Kohlekraftwerken soll CO2 nicht mehr in die Atmosphäre entweichen, sondern in unterirdische Lager gelenkt werden. Das ist allerdings ein sehr aufwändiges, kostspieliges und umstrittenes Unterfangen.
Das Einlagern von Biokohle sei hingegen eine robuste, einfache und schnell umsetzbare Technik, die sich für viele Regionen der Welt eignen würde, betont Johannes Lehmann, der mit Bruno Glaser das Geheimnis der Terra Preta entschlüsselt hat und heute an der Cornell University in New York forscht. Wirtschaftlich lohne sich diese Lösung allerdings nur, wenn günstige Reststoffe verfügbar seien und die Biokohle im CO2-ZertifikateHandel zugelassen werde, sagt der Wissenschaftler. Solche Zertifikate für einge-
Fasten-Wandern-Wellness
FastenistderInbegriffderErholung. IdaHofstetter,Tel.0449211809 www.fasten-wandern-wellness.ch
Zeigt die Summe der Kräfte in Körper-Seele-Geist. Mehrfarbig, Kalenderform, Taschenformat, 12 Monate Fr. 36.–. Bitte Geburtsdaten an: Hermann Schönenberger, Churerstr. 92 B, 9470 Buchs SG Telefon 081 740 56 52, bioschoen@bluewin.ch

ErholungauchfürwenigGeld? KreativeFerienwochenimEinklangmitderNatur aufaltemBauerngutinderProvence. Erlebnisreich,herzhaft,persönlich. Info:0447716979,www.ForumMusik.ch
FürunserbiologischgeführtesHotel-Garni ineinembekanntenOstschweizerTourismusOrtsuchenwir eine/nKäufer/in sehrguterGästestamm. VBCHF1800000.–inkl.Inventar. Telefon0798529258


Trauerseminare
Trauerseminare
043/8193732
043/8193732


ballbed ® Information/Unterlagen ball bed®, M. Stöckli, 6828 Balerna Tel. 091 683 91 77, Fax 091 683 02 81 www.ballbed.com, E-mail mstockli@tinet.ch
Meditations-Seminare mit dem indischen Yogi Dhirananda Ursprünglicher Kriya Yoga aus der Linie von Babaji bis Paramahansa Yoganandaji und Paramahansa Hariharanandaji Infos unter: www.kriya-yoga.net Tel./Fax: 056 222 98 56, E-Mail: office@kriya-yoga.net Kryia_bearbeitet.indd 1







Das abgeschiedene, ökologische Paradies für Familien, Seminare und Individual-Urlauber. Hotel Finca El Cabrito Telefon 0034-922-14 50 05, www.elcabrito.es


Visionary Craniosacral Work GmbH

Hugh Milne – Visionäre CraniosacralTherapie, Weiterbildung VCSW GmbH,Rainstr.241,8706 Meilen, Tel./Fax 044 793 44 55,VisionaryCSW@hotmail.com 32140-01
Eigene Schreinerei Massivholz- Küchen - Betten - Möbel - Kindermöbel
Natur- Matratzen -Bettwaren

Möbel zum verlieben
• Chelat-Therapie z. B. bei Schwermetallentgiftung Durchblutungsstörungen
• Hydro-Colon Darmreinigung
• Sauerstoff-Therapien Ozon-Oxyvenierung
Naturheilpraxis Hp. Ludwig Rothenberger Brauneggerstrasse 7, D-78462 Konstanz Tel. 0049-7531-21496 www.naturheilpraxis-bodensee.de
Webzeitschrift mit Kummerbox
www.christinafriedli.ch
Zuverkaufen im sonnigenFricktal zw.Zürich–Basel: baubiol.saniertes ehem.Bauernhaus. 7,5Zimmer=250m2. ElfingenAG. BesterZustand.GrossesAusbaupotenzialderScheune(1027m3). Holzzentralheizungprogrammierbar. KeinNatelempfang,allergikerfreundlich.GeeignetfürgrosseFamilie, Wohngemeinschaft,Wohnen/Büro/ Atelier.
Grundstück936m2.Preis990000.–. Fam.Portmann,Telefon0614215910. E-Mail:beatrice.portmann@bluewin.ch
Behandlungen Seminare,Ausbildungen
seit2004inOlten,Tel+41(0)763988686 nur30minabBasel,Bern,Luzern,Zürich ayurquell.ch|ayurveda-kurse.ch AyurvedaGesundheitszentrum
HabensieSchmerzenimBewegungsapparat undkeineTherapiehatbishergeholfen? DieLNB-Schmerztherapieerklärtihnenwarumundwiesie wiederschmerzfreiwerden.InderRegelreichenbereits 3–5Behandlungenaus.HilftauchbeiArthrose, rheumatischenSchmerzen,Rückenschmerzenetc. PraxisfürchinesischeMedizin
Kasernenstrasse99100HerisauTel.0713517801 Infosunter:www.liebscher-bracht.com
sparte Treibhausgasmengen wurden im Rahmen des Kyoto-Protokolls eingeführt.
Treibhausgase im Boden versenken und damit gleichzeitig die Ernten steigern – das tönt nach einer Patentlösung. Doch wenn diese Art Klimaschutz wirtschaftlich attraktiv wird, könnte die Chance auch zu einem Risiko werden. Wie beim Anbau von Pflanzen für Biotreibstoffe im grossen Massstab könnten dabei intakte Naturlandschaften Kulturen schnell wachsender Biomasse weichen und sich Monokulturen mit allen ihren ökologischen Problemen ausbreiten. Klimazertifikate für Biokohle sind deshalb an strenge Auflagen zu knüpfen.
Pilotprojekt Weinbau
Noch braucht es allerdings Forschung, um überhaupt abzuklären, wie sich Biokohle im grösseren Stil optimal produzieren und einsetzen lässt. Daran arbeitet zurzeit ein Netzwerk bestehend aus schweizerischen und deutschen Forschungsinstituten. Folgende Fragen stehen dabei im Zentrum: Wie entstehen bei der Produktion möglichst wenig Emissionen? Wie vermeidet man, dass Schadstoffe in die Biokohle und damit in den Boden gelangen? Wie entwickeln sich Bodenleben, Bodenstruktur und Wachstum der Kulturen? Verändert sich die Qualität des Ernteguts?
Zugpferd des «Forschungsnetzwerks Biokohle» ist das neu gegründete Institut für Ökologie und Klimafarming des Biowein-Produzenten Delinat in Arbaz (VS) mit seinem Leiter Hans-Peter Schmidt. Auf dem instituteigenen Weingut Mythopia machten die Forscher 2008 und 2009 erstmals Anbauvergleiche. Mitarbeiter säten im Frühling Leguminosen zwischen die Reben, versorgten einen Teil dieser Streifen zusätzlich mit Kompost und einen anderen Teil mit einem Gemisch aus Kompost und Biokohle.
Die Resultate bezeichnet Schmidt als sehr erfreulich: «Die Reben werden durch die kombinierte Düngung optimal ernährt.» Im Kohle-Versuchsstreifen nah-

Die Schweizer Biokohle-Pioniere sind interessiert, auch in Privatgärten Erfahrungen mit dem neuen Material zu sammeln.
Das Institut für Ökologie und Klimafarming gibt deshalb Biokohle an interessierte Hobbygärtner ab. Bedingung ist, dass diese über Anwendung und Resultate ein Protokoll führen.
_ www.delinat-institut.org
men die Reben laut Schmidt mehr Stickstoff auf und die Wuchskraft der Reben war entsprechend besser.
Begeistert äussert er sich zu zwei weiteren Ergebnissen: «Die Trauben enthalten deutlich mehr Polyphenole, also Aromastoffe, was sich auf die Qualität des Weins positiv auswirkt.» Zudem bildeten sich mehr Aminosäuren. Diese fördern die Gärung und können die Anfälligkeit der Reben für Krankheiten senken. Offenbar speicherten die mit Kohle angereicherten Böden auch mehr Wasser und blieben während Trockenperioden deutlich grüner. Topfversuche im Labor der Universität Zürich sollen zum Speichervermögen nun genauere Daten liefern.
In den bisherigen Anbauvergleichen kam gewöhnliche Holzkohle zum Einsatz. Wenn stattdessen ein optimiertes Produkt aus Pyrolyse verfügbar sei, rechne er damit, dass sich die positiven Effekte noch verstärkten, so Schmidt. Ab 2010 steht durch Pyrolyse gewonnene Biokohle für sämtliche europäischen Forschungsprojekte zur Verfügung. Denn im Januar nahm in Belmont bei Lausanne die Pyrolyse-Anlage Swiss Biochar, an der auch Delinat einen Aktienanteil hält, die Produktion auf.
Noch muss das Verfahren optimiert werden. Erprobt wird beispielsweise, welches der ideale Zeitpunkt ist, Biokohle dem Kompost beizufügen. Denn Biokohle darf nicht direkt in den Boden eingebracht
werden, wenn sie sofort optimal wirken soll. Sie würde dort die Nährstoffe an sich binden, sodass diese den Pflanzen fehlen würden. Wenn sie hingegen während des Verrottungsprozesses in die Kompostmiete kommt, entsteht eine segensreiche Verbindung. Ihre porenreiche Oberfläche speichert mineralische Komponenten und aktiviert das Bodenleben. «Im Boden wirkt die Biokohle dann wie ein Kühlschrank, aus dem die Pflanzen mithilfe von Bodenpilzen rausholen können, was sie brauchen», erklärt Schmidt. u
Surftipps
_ www.natuerlich-leben.ch/surftipps

Pyrolyse: Aus organischem Material entsteht Biokohle.
























































































































Markt
Markttag der Gimmelwaldner
Märitfrauen
Neben dem Restaurant Stägerstübli
Ab 9.00 Uhr, Mürren
Tel. 033 856 86 86 info@muerren.ch http://www.mymuerren.ch
Ostermarkt Arbon 27. 3. 2010, auf dem Fischmarktplatz
Infocenter Arbon Tel. 071 440 13 80 info@infocenter-arbon.ch www.infocenter-arbon.ch
Ostermärit Wengen
Klein, aber fein 1. 4. 2010, 9 –16 Uhr, auf dem Eigerhubel
Wengen Tourismus Tel. 033 855 14 14 info@wengen.ch www.wengen.ch
Wintermarkt
Gstaad, beim Kapälliplatz 3. 4. 2010, 11 –18 Uhr
Patricia Grünigen Ebnit, 3780 Gstaad Tel. 033 744 78 83
Schlaraffia Wein- und Gourmetmesse 11.–14. 3. 2010, Weinfelden Tel. 071 626 33 55 info@schlaraffia-messe.ch www.schlaraffia-messe.ch
Kultur
«Niid dergliche tuä» Live-Hörspiel im Stockdunkeln 7. 3. 2010, 20.30 Uhr Tel. 062 871 81 88 info@ meck.ch Meck, Geissgasse 17, 5070 Frick
Konzertreihe: Aura Ensemble 13. 3. 2010, 19.30 Uhr Festsaal Kloster in Muri AG
Tel. 056 664 70 13 sekretariat@murikultur.ch www.murikultur.ch www.auraquartett.ch
Oster Tango 2010
11. Internationales Tango-Festival
28. 3 – 5. 4. 2010, Volkshaus Basel tangobasel@tangobasel.ch www.tangobasel.ch
Apassionata –Zauber der Freiheit
27. 3. 2010
St. Jakobshalle Basel
Act Entertainment AG
Paulusgasse 16, 4011 Basel Tel. 061 226 90 00 act@actentertainment.ch www.topact.ch
Historische Osterprozessionen 1.– 2. 4. 2010, Mendrisio
Mendrisiotto Tourismo Tel. 091 646 57 61 info@mendrisiotourism.ch www.mendrisiotourism.ch
Sol Gabetta
Benefizkonzert
25. 3. 2010, 19.30 Uhr Stadtcasino Basel
Tel. 0900 585 887 (Fr. 1.20/Min) info@kulturticket.ch www.kulturticket.ch
Auf der Alp Fotografien von Nicolas Repond
Bis zum 25. 4. 2010 Schloss Greyerz Tel. 026 921 21 02 chateau@gruyeres.ch www.schloss-greyerz.ch
Museumsnacht Bern 19. 3. 2010, 18 – 2 Uhr
Bern Tourismus Center im Bahnhof Tel. 031 328 12 12 info@berninfo.com www.museumsnacht-bern.ch
Wechseljahre II
Homöopathische Behandlung von Wechseljahrsbeschwerden
6. 4. 2010, 19 – 21.30 Uhr Kosten: Fr. 30.–
SHI Haus der Homöopathie Steinhauserstrasse 51, 6300 Zug
EPD-Ernährungsprogramm 15. 3. 2010, 19 Uhr
SPA Medical Wellness Center Badstrasse 25 5330 Bad Zurzach Tel. 056 265 28 00 info@medical-wellness-center.ch www.medical-wellness-center.ch
Die Stimme des Herzens 9.–11. 4. 10, 17.15 –13.30 Uhr Atem – Körperarbeit –Meditation
Stella Matutina Bildungshaus Hertenstein bei Weggis Tel. 052 212 14 62 Beatrice Baumeister und Giacomo Künzler www.atempraxis-winterthur.ch
Klang-Perlen suchen 12.–14. 3. 2010 Sunnehus
Kur- und Bildungszentrum Moos Tel. 071 998 55 55 www.sunnehus.ch info@sunnehus.ch
Seelenrückholung 3.–7. 3. 2010
Villa Kassandra in Damvant Tel. 061 312 94 80 info@womenandearth.ch www.womenandearth.ch
Einführung in Ayurveda 10. April 2010 Vastu, das indische Feng Shui 17. April 2010 ayurQuell 4600 Olten, Tel. 076 398 86 86 www.ayurveda-kurse.ch www.ayurquell.ch
Auf zur Kraft der Mitte Boden finden, den Rücken entlasten, den Kopf befreien Kurs für Männer 20. 3. 2010 von 9.30–12.30 Uhr Kosten: Fr. 340.–DAO, Beat Hänsli, Gesellschaftsstrasse 81a, 3000 Bern 9 taichidao@bluewin.ch Tel. 031 302 55 65 Natel 079 443 85 88 www.taichidao.ch
Yogaferien im Tessin Mehr Energie und Wohlfühlen! 18.–23. 4. 2010
Yogaschule Antonia Somm Kleinbuchbergweg 6 8200 Schaffhausen
Tel. 052 640 10 01 www.mehrenergie.ch
Das Quintett der Religionen 20./21. 3. 2010
Tagungshaus Rügel, Seengen Anmeldung bis 5. 3. 2010 kurse@ruegel.ch
Tel. 062 767 60 54 www.ruegel.ch www.religionenquintett.ch
Fasten – Wandern – Wellness 14.–21. 3. und 17.– 24. 4. und 25. 4.– 2. 5. 2010
Ida Hofstetter
Neuhofstr. 11, 8708 Männedorf
Tel. 044 921 18 09 www.fasten-wandern-wellness.ch info@fasten-wandern-wellness.ch
Fastenwandern im Wunderland Schweiz
Ascona, mit Liselotte Güntert, 1712 Tafers 6.–13. 3. und 14.– 21. 3. 2010
Tel. 026 494 25 79 www.fastenwandern.chh
Frühlingserwachen
Botanische Exkursion im Naturpark Thal, 11. 4. 2010 Anmeldung bis 8. 4. 2010 Kosten: Fr. 90.–crenatura@bluewin.ch
Tel. 032 641 08 87
Meditative Fastenferien –ein Weg zum Neubeginn Parkhotel Beatenberg 3.–10. 4.; 10.– 17 4.; 17. 4.– 24. 4.; 24. 4.–1. 5. 2010
Essenz-Institut
8260 Stein am Rhein
Tel. 052 741 46 00 www.fasten.ch
Metabolic Typing –Optimale Ernährung dank Stoffwechseltypisierung 10. 3. 10
Wohlfühlwoche –fasten und wohlfühlen 13.– 20. 3. 10 Ernährungsworkshop 8. 4. 10
OTMARSAN AG
Kurhaus St. Otmar
Rigiblickstrasse 98, 6353 Weggis
Tel. 041 392 00 10 www.otmarsan.ch
Nichtraucherin Öko-Lisa sieht dem kommenden Schweizer Rauchverbot gelassen entgegen –und hat Ideen, wie Wirte ihre Umsatzrückgänge kompensieren könnten.

Die Journalistin und Moderatorin Nicole Amrein hat mehrere satirische Frauenromane und Romanserien verfasst, darunter einige Bestseller. Jeden Monat gewährt uns die Bernerin mit spitzer Feder einen unterhaltsamen und intimen Blick ins Tagebuch von Öko-Lisa. _ www.nicoleamrein.ch
Es fällt mir deshalb leicht, mit dem Genussrauchen aufzuhören, weil ich nie damit angefangen habe. So blicke ich dem 1. Mai 2010 gelassen entgegen. Dem Tag, an dem das Rauchverbot schweizweit in Kraft treten wird. Ich kann auch gut damit leben, wenn einzelne Kantone das neue Gesetz nur als Untergrenze ansehen und innerhalb ihres Hoheitsgebietes noch strengere Vorschriften erlassen. Zum Beispiel könnte man die russische Praktik aus den Anfängen des 17. Jahrhunderts wieder aufleben lassen, wo der Tabakkonsum vom Klerus als Todsünde angesehen und mit dem Aufreissen der Nase beziehungsweise dem Aufschneiden der Lippen bestraft wurde. Man kann es auch schlicht dabei belassen, die Süchtigen bei jedem Wind und Wetter vor die Tür zu verbannen und dadurch von offizieller Stelle dem Smirting Vorschub leisten.
_Lesen Sie im nächsten Heft: Wer zuletzt lacht
Smirting ist ein Konstrukt aus den beiden Wörtern Smoking und Flirting. Als solches bezeichnet es nicht weniger als das Flirten während des Rauchens vor Gebäuden, in denen der Konsum von Tabak strikte untersagt ist. Unsere südlichen Nachbarn hatten Smirting schon perfektioniert, da war vom Rauchverbot in Italien noch keine Rede. 2005 eingeführt, gilt es im Übrigen als eines der Restriktivsten in ganz Europa. Vor Smirting genoss man noch die Zigarette nach dem Sex. Im Zuge des Nichtraucherschutzes gibts zuerst die Zigarette, dann das Schäferstündchen –vorausgesetzt, die Beteiligten sind dazu noch in der körperlichen Verfassung. Denn
Rauchen kann zu Impotenz führen. Zu Atemwegserkrankungen. Zu Gefässverengungen. Im schlimmsten Falle zum Tod. Nun raucht ja wohl niemand, um früher von dieser Welt zu gehen. Nicht mal die Menschen im Süden von Laos, bei denen es völlig normal ist, dass selbst die kleinsten Kinder schon am Glimmstängel hängen, noch ehe sie laufen können. Auch als «Volk der Särge» bekannt, schnitzten die Stammesmitglieder der Kha Loum und Alak bereits zu Lebzeiten ihre ganz persönlichen Särge. Was zuerst war – die Tradition des eigenen Sargschnitzens oder die französischen Kolonialherren, welche die ersten Tabakpflanzen auf das BolavenPlateau gebracht haben – ist ähnlich der Frage vom Huhn und vom Ei nicht abschliessend geklärt.
Fakt ist: Argumente fürs Schloten sind in etwa so schwierig zu finden, wie jene Barbesitzer, die dem Rauchverbot in ihren Lokalen positiv gegenüberstehen. Von verheerenden Umsatzeinbrüchen ist die Rede, von drohenden Betriebsschliessungen. Im äussersten Notfall können wir in der Schweiz immer noch dem italienischen Beispiel folgen und unsere Wirtinnen und Wirte umschulen. Zu Hilfspolizisten, die per Gesetz dazu verpflichtet werden, die Einhaltung des Rauchverbots in ihren Lokalen gegenüber den Gästen durchzusetzen. Bei Verstoss drohen bis zu 3000 Franken Busse.
Und wenn dann das Rauchen in öffentlichen Bereichen eines dunstfreien Tages kein Thema mehr sein sollte, so können die zuständigen helvetischen Stellen das Verbot ja immer noch auf den Alkohol ausdehnen. Oder auf die TransFettsäuren. Oder die Mono und Disaccharide beziehungsweise den Genuss schlechthin. u

SchulefürSterbe-undTrauerbegleitung
Berufsbegleitende ein-oderzweistufige Ausbildungmitnamhaften Gastdozenten:
AnoukClaes,PeterGoldman, JürgNeuenschwander,PyarTroll, DollyRöschli,KurtNägeli, AnnetteKaiser,ElisabethBond, HeidiBrüederli,StefanFäsch, NelHoutman,u.a.
NächsterAusbildungsbeginn: 3.März2010 undEndeAugust2010
«DieTränenderFreude undderTrauer fliessenausderselbenQuelle»
ZentrumJemanja Ifangstrasse3,Maugwil 9552Bronschhofen Telefon0719110367 info@jemanja.ch www.jemanja.ch
bed and breakfast borgopescatori
schautauf’smeer sommerundwinter
margheritaflück 73030tricaseporto(lecce)italia tel.0039083377 5121 margheritaborgopesca@libero.it www.borgopescatori.eu
Stephan Kuhn Planung und Realisation von naturnahen Gärten
Huenerwadelgasse14Jurastrasse 23 5034 Suhr 3013 Bern Tel.0795306138Tel.031333 26 27

Naturheilkundliches Therapiezentrum RUWASCA

Raucherentwöhnung Colon-Hydro-Therapie Migräne u. Spannungskopfweh phone: 062 923 57 60 home: www.ruwasca.ch mail: info@ruwasca.ch Rücken- u.Gelenkprobleme

SanfteKräftederNatur ToniHalterEnergieprojekte BErEiTfürdEnfrüHling? Kupfer-Gartengeräte www.energieprojekte.ch 0416608891





BEA-Verlag 5200 Brugg 056 444 22 22 bea-verlag.ch

































RZ_011_BioStrath_Gelegenheitsins_4f_coated.indd 1 07.12.09 10:51



30. Jahrgang
«natürlich leben» erscheint 12x jährlich
Druckauflage: 50 000 Exemplare
Abonnement: 1 Jahr Fr. 84.–inkl. MwSt. 2 Jahre Fr. 148.–
Ausland: zuzüglich Porto Einzelverkauf: Fr. 8.–
Abonnementsbestellungen
Telefon 058 200 55 62 abo@natuerlich-leben.ch
«natürlich leben» im Internet www.natuerlich-leben.ch
Redaktion und Verlag AZ Fachverlage AG
Redaktion «natürlich leben»
Neumattstrasse 1, 5001 Aarau
Telefon 058 200 56 50, Fax 058 200 56 51
Redaktion:
Markus Kellenberger, Chefredaktor markus.kellenberger@natuerlich-leben.ch
Andres Jordi andres.jordi@natuerlich-leben.ch
Leserberatung: Sabine Hurni sabine.hurni@natuerlich-leben.ch
Mitwirkende an dieser Nummer: Nicole Amrein, Martin Arnold, Veronica Bonilla, Regine Elsener, Urs Fitze, Heini Hofmann, Heinz Knieriemen, Martin Koradi, Simon Lipsig, Beatrix Mühlethaler, Remo Vetter
Layout: Fredi Frank
Verleger: Peter Wanner
Verlagsleitung: Dietrich Berg
Leitung Lesermarkt/Online: Peter Jauch Leitung Werbemarkt: Jürg Rykart juerg.rykart@azmedien.ch
Telefon 058 200 56 04
Anzeigen
Natürlich, Inserateverkauf
Webereistrasse 66, 8134 Adliswil cebeco@bluewin.ch, Fax 044 709 19 25
Christian Becker
Telefon 044 709 19 20
Rolf Ulrich
Telefon 044 710 19 91
Anzeigenadministration: Nicole Flückiger
Telefon 058 200 56 16 nicole.flueckiger@azmedien.ch
Grafisches Konzept: artdepartment.ch
Herstellung
Vogt-Schild Druck AG Gutenbergstrasse 1, 4552 Derendingen
ISSN 1663-4799
Über unverlangt eingesandte Manuskripte wird keine Korrespondenz geführt.
Wiedergabe von Artikeln und Bildern nur mit ausdrücklicher Genehmigung des Verlages.

Bedroht
Amphibien gehören zu den am stärksten gefährdeten Tieren der Welt. In der Schweiz stehen 70 Prozent auf der Roten Liste. Schuld daran trägt vor allem der Mensch – aber nicht nur er.

Bewegend
Fastenwandern ist keine Betätigung grenzgängerischer Spinner, sondern ein ganzheitliches Körpererlebnis – und hat Tradition.

Bekömmlich
Ab April schiessen sie wie Pilze aus dem Waldboden – die Morchelsaison ist eröffnet. Der Speisepilz ist hierzulande heiss begehrt.
l Tierpsychologie l Barfuss durchs Appenzell wandern l Was gegen Läuse hilft l Unterwegs mit der Tibetbahn
«natürlich leben» 4-2010 erscheint am 26. März 2010
Kontakt Aboservice: Telefon 058 200 55 62, Fax 058 200 55 63 oder abo@natuerlich-leben.ch, www.natuerlich-leben.ch

Simon Libsig über Finger-Edi, der seine Behinderung zu pädagogischen Zwecken einsetzt – und womöglich lieber die Wahrheit gesagt hätte.
zittriger Hand griff er nach der elektrischen Gartenschere und schlich damit ums Haus herum zum Haselstrauch. Es würde nur ganz kurz dauern. Den geeigneten Ast für seinen Pfeilbogen hatte er schon vor Tagen ausgesucht, nun würde er ihn so leise wie möglich abschneiden und die Schere dann sogleich wieder zurücklegen. Vater würde nichts merken. So der Plan. «Chrrrrrrrrrr», schnurrte die Gartenschere, und dann merkten es dann leider doch alle. Zuerst der Nachbar, der den Schrei hörte, dann die Eltern und die Schwester, und als die Ambulanz mit Blaulicht und Sirene und mit ihm davonbrauste, wusste es wohl bereits das halbe Dorf.
Wackeln mit dem Finger, gefolgt von einem « Mei-mei-mei » hat noch so manchen Rotzlöffel diszipliniert.
Die Behinderung war ihm nicht lästig, sie war ihm ein wertvolles pädagogisches Hilfsmittel, und er setzte es gekonnt ein. Je nach Lektion, die er lehren wollte, erzählte er eine andere Geschichte, wie es denn zu diesem halben Finger gekommen sei. Mal war es der gefährliche Hund, den man nicht hätte streicheln sollen, mal das Hantieren mit Feuerwerk und einmal sogar die harte aber gerechte Strafe für einen Melonen-Diebstahl. Er war richtig erfinderisch, der Finger-Edi, aber nur mit den besten Absichten.
«Die Behinderung war ihm nicht lästig, sie war ihm ein wertvolles pädagogisches Hilfsmittel.»
Für seinen Sohn hatte er sich dann eine ganz besondere Geschichte ausgedacht: «Dieser Finger», sagte er dem bald Fünfjährigen, «der ist mir damals abgebrochen!» Und dann wartete er, ganz Pädagoge, bis die Augen seines Sohnes grösser wurden und sich sein Mund etwas öffnete, und fügte dann mit Nachdruck hinzu: «Weil ich als kleiner Junge immer in der Nase bohrte!»
Sein rechter Zeigefinger, oder besser der kümmerliche Rest, der davon übrig geblieben war, wurde bald zu seinem Markenzeichen. Nun war er Finger-Edi, und wenn er seinen kleinen Stumpf etwas in die Höhe streckte und gleichzeitig seine Augenbrauen hochzog, dann endeten die Gespräche rundherum abrupt. Dann war Ruhe. Dann hatte er die ungeteilte Aufmerksamkeit. Dass er später Lehrer wurde, war nur konsequent. Was auch immer er mit erhobenem halbem Zeigefinger von sich gab, schien doppelt an Bedeutung zu gewinnen. Wenn er auf jemanden zeigte, dann erbleichte dieser nicht selten. Und sein tadelndes
Der Trick hatte einwandfrei funktioniert. Nie hätte es der Junge gewagt, seine Finger auch nur in die Nähe seiner Nase zu bewegen. Auch später nicht, als ihn das Verbotene speziell zu reizen begann, als er sich als Indianer-Häuptling in gefährliche Abenteuer stürzen wollte. Nein, popeln war kein Thema. Aber eines Tages griff er mit zittriger Hand nach der elektrischen Gartenschere und schlich damit ums Haus herum zum Haselstrauch. u
Simon Libsig (1977) kann lesen und schreiben. Mit dieser Fähigkeit gewann der Badener bereits mehrere Poetry Slams und den Publikumspreis Swiss Comedy Award 2009. Zurzeit ist er mit seinem neuen Solo-Programm «Sprechstunde» auf Tournee. Mehr Info dazu auf www.simon-libsig.ch